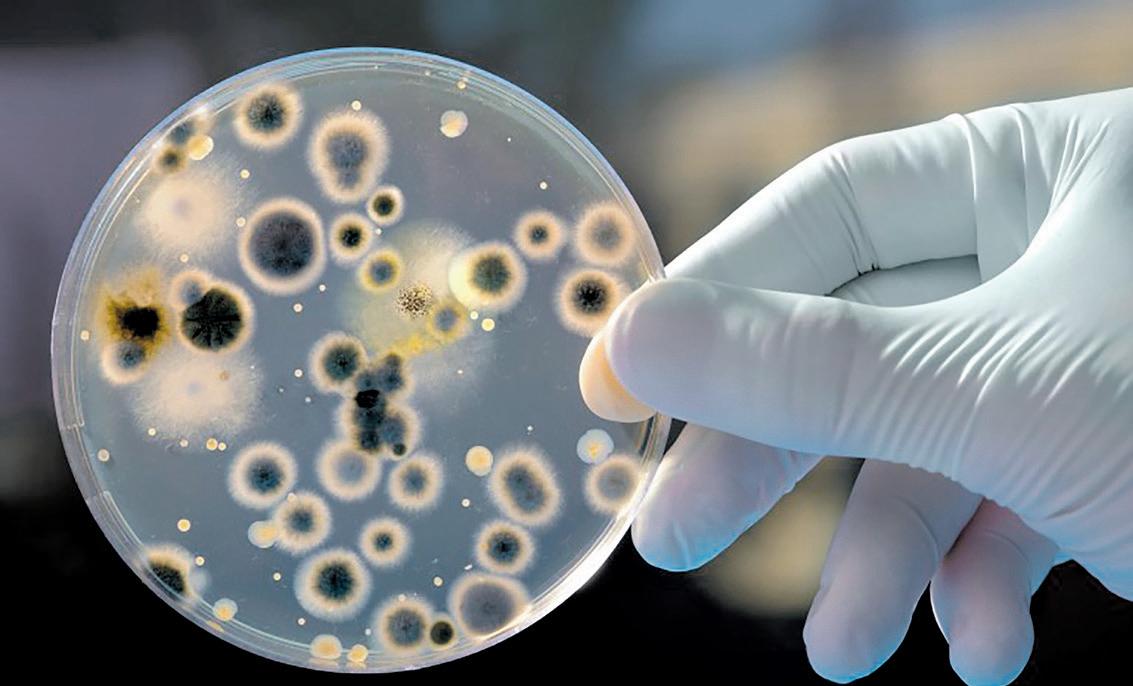

ANO XXIV NÚMERO 396
Março 2024

AVALIAÇÃO DO REPARADOR PÁG. 14

MERCADO
Veja como foi o movimento das oficinas mecânicas no último boletim do Pulso do Aftermarket!
PÁG. 6
CONSULTOR OB
Motores a combustão, híbridos e elétricos, Inteligência Artificial e Aprendizado de

PÁG. 36
DIRETO DO FORÚM LANÇAMENTO
O que a nova picape média Fiat Titano tem diferente das concorrentes?
Confira! PÁG. 12
Confira os principais passo a passo técnico com os grandes especialistas do Fórum Oficina Brasil
PÁG. 54




TITANO
EDITORIAL 2

DIRETOR GERAL
André Simões
GERENTE COMERCIAL
Carlos Souza
GERENTE DE NOVOS NEGÓCIOS Átila Paulino
GERENTE DE REDAÇÃO
Wellyson Reis
GERENTE DE PERFORMANCE
Shelli Braz
GERENTE DE TI
Tiago Lins
PUBLICIDADE
Julianna Miras – Executiva de Contas
QUALIFICAÇÃO DE ASSINANTES
Talita Assis - Auxiliar de Atendimento
DESIGNER
Daniel Victor
PRÉ-IMPRESSÃO E IMPRESSÃO
Margraf Editora e Indústria Gráfica Ltda.
DEMANDA DE CARROS ELÉTRICOS
Para os leitores mais atentos estamos dedicando este editorial para um assunto que iniciamos na edição passada, os carros elétricos.
A demanda de carros elétricos traz inúmeros desafios e oportunidades para o nosso mercado de reposição. Em linhas gerais, especialistas apontam que a demanda de peças reduzirá sete vezes em relação á de um carro a combustão. Isso torna o Aftermarket interessante pela ótica das indústrias e seletiva para aqueles reparadores que saíram na frente e estão aptos a reparar este tipo de veículo.
No passado tivemos uma mudança significativa no sistema de alimentação dos motores a combustão, ou seja, saímos do antigo carburador e os carros receberam a injeção eletrônica.
FALE CONOSCO
ATENDIMENTO AO LEITOR
Talita Caroline Assis leitor@oficinabrasil.com.br
De 2° a 6°, das 8h30 às 18h
Tel. (11) 2764-2881
PUBLICIDADE anuncie@oficinabrasil.com.br
ON-LINE wellyson.reis@oficinabrasil.com.br
RH rh@oficinabrasil.com.br
FINANCEIRO financeiro@oficinabrasil.com.br
CINAU cinau@oficinabrasil.com.br
CARTAS
Rua: Alameda Santos, 1800 - 5° Andar São Paulo - SP, CEP: 01418-102


Outras mudanças mais recentes estão relacionadas às evoluções do sistema de freio com incremento do ABS, introdução do conceito downsize e outras evoluções como motores com injeção direta e turboalimentados, tecnologias presentes na F1.
Voltando aos carros elétricos, as vendas de veículos elétricos leves em 2023 cresceram 91% em relação a 2022, segundo a ABVE (Associação Brasileira de Veículos Elétricos). Hoje a frota nacional de veículos elétricos representa cerca de 0,5% do total da frota circulante do país, mas a projeção da Bright Consulting aponta que até 2030 os veículos elétricos representarão cerca de 10% da frota brasileira.
Uma das barreiras para este crescimento da frota está relacionada à infraestrutura de carregamento, hoje são poucos pontos de carregamentos em relação à quantidade de postos de gasolina. De acordo com a ANP (Agência
Oficina Brasil é uma publicação (mala direta) do Grupo Oficina Brasil (ISSN 2359-3458). Trata-se de uma mídia impressa baseada em um projeto de marketing direto para comunicação dirigida ao segmento profissional de reparação de veículos. Circulando no mercado brasileiro há 35 anos, atinge de forma comprovada 71% das oficinas do Brasil. Esclarecemos e informamos aos nossos leitores, e a quem possa interessar, que todos os conteúdos escritos por colaboradores publicados em nossa mala direta são de inteira e total responsabilidade dos autores que os assinam. O Grupo Oficina Brasil verifica preventivamente e veta a publicação de conteúdo, somente no que diz respeito à adequação e ao propósito a que se destina, e quanto a questionamentos e ataques pessoais, sobre a moralidade e aos bons costumes.
As opiniões, informações técnicas e gerais publicadas em matérias ou artigos assinados não representam a opinião deste veículo, podendo até ser contrárias a ela.
Nós apoiamos:
Filiado a:





Nacional do Petróleo), o país contava com cerca de 41.808 postos revendedores de combustíveis em 2021 e de acordo com a ABVE (Associação Brasileira de Veículos Elétricos) o território brasileiro possuía cerca de 3.800 postos de carregamento de carros elétricos em 2023. Outra barreira para o crescimento da frota está relacionada ao constante aumento de impostos sobre os veículos elétricos e importados, pois até julho de 2026 a alíquota será de 35%, o que pode tornar a diferença entre o carro a combustão e o elétrico ainda maior.
Mas e as oficinas? As oficinas terão um desafio ainda maior.
Primeiro de capacitação e segundo os equipamentos específicos. Sem o devido cuidado há um risco emitente na manutenção destes carros. E isso tem que ficar muito claro para você amigo reparador, pois caso seja aplicado um procedimento incorreto este pode custar a tua vida. Sendo assim, diferentemente das mudanças que ocorreram entre carburadores e injeção eletrônica, freio convencional para ABS, motores aspirados para turbinados, o carro elétrico implica em conhecimentos específicos (treinamentos), infraestrutura necessária, ferramentas especiais e equipamentos de proteção individual. Qualquer ponto fora desta realidade poderá incorrer em graves acidentes.
Então fica aqui o nosso alerta quanto à reparação dos veículos elétricos e recomendamos a você profissional da reparação muita cautela na reparação destes carros.
BOA LEITURA!
GRUPO OFICINA BRASIL
DADOS DESTA EDIÇÃO
• Tiragem: 55.000 exemplares;
• Distribuição nos correios: 54.400 (até o fechamento desta edição)
• Percentual aproximado de circulação auditada (IVC): 98,9%
COMPROMISSO COM O ANUNCIANTE - GARANTIAS EXCLUSIVAS NO MERCADO DE MÍDIA IMPRESSA Oficina Brasil oferece garantias exclusivas para a total segurança dos investimentos dos anunciantes. Confira abaixo nossos diferenciais: 1º. Nossa base de assinantes é totalmente qualificada por um sistema de “permission marketing” que exige do leitor o preenchimento de cadastro completo e que prove sua atuação no segmento de reparação;
2º. Atingimos, comprovadamente, 53 mil oficinas, o que equivale a 71% dos estabelecimentos da categoria no Brasil;
3º. Possuímos Auditoria permanente do IVC (Instituto Verificador de Comunicação), garantindo que a mala direta está chegando às mãos do assinante qualificado;
4º. Registro no Mídia Dados 2020 como o “maior veículo do segmento do País”;
5º. Único veiculo segmentado que divulga anualmente o CUSTO DE DISTRIBUIÇÃO. Este número é auditado pela BDO Brasil e em 2021 o investimento em Correio foi de R$ 1.373.346,51 (hum milhão, trezentos e setenta e três mil, e ciquenta e um centavos), para garantir a entrega anual em nossa base qualificada de oficinas;
6º. Estimulamos nossos anunciantes à veiculação de material do tipo “Call to Action” para mensuração do retorno (ROI);
7º. Certificado de Garantia do Anunciante, que assegura o cancelamento de uma programação de anúncios, a qualquer tempo e sem multa, caso o retorno do trabalho (ROI) fique aquém das expectativas do investidor.

Março 2024 • oficinabrasil.com.br
www.oficinabrasil.com.br

ÍNDICE 4
MERCADO
Acompanhe mais um boletim exclusivo do Pulso do Aftermarket
ENTREVISTA
Confira a trajetória de Keli Osako, diretora de vendas da Gates
LANÇAMENTO
A Fiat Titano é a nova aposta da montadora Italiana!
AVALIAÇÃO DO REPARADOR
Megane E-Tech, o SUV da Renault passou pela avaliação dos nossos reparadores
FUNDO DO BAÚ
Ford Escort XR3, o modelo que resultava da parceria entre Ford e Volkswagen
EVENTO
A Fórmula E desembarca em São Paulo com um olhar para o futuro sustentável
GESTÃO
Recepcionar o cliente e saber ouvi-lo te ajudará na correta execução do serviço
REPARADOR DIESEL
Turbina de geometria variável, alta velocidade dos gases em baixas rotações
TURBOS
Válvula Blow-off, já ouviu falar desse componente e sua função nos motores?
TECNOLOGIA
Conheça sobre transportes autônomos que tem sido muito utilizado nas cidades
CONSULTOR OB
Veja os últimos avanços tecnológicos na indústria automotiva
TÉCNICA
O analisador de falhas apresenta testes que auxiliam e aceleram o diagnóstico
DO FUSCA AO TESLA
Veja como interpretar o esquema elétrico em diversas formas
DIRETO DO FÓRUM
Confira os casos de maior destaque do Fórum Oficina Brasil

Eletricidade nas Pistas: A Jornada Rumo à Sustentabilidade e Velocidade na Fórmula E 12


ENTREVISTA EVENTO
Vinte anos de paixão por carros: Confira a história de Keli Osako, diretora de vendas da Gates. Ela nos conta sobre sua trajetória e a visão da empresa

CONSULTOR OB
Na matéria deste mês vamos mostrar como o uso de diferentes equipamentos e testes específicos proporcionam uma sequência lógica de diagnóstico


TÉCNICA
Continue explorando as manutenções em unidades de bombeamento dos sistemas de pós-tratamento SCR
14
Março 2024 • oficinabrasil.com.br 6 08 12
Pág. 42
52 08 36 24 28 26 :: Números CAL (Central de Atendimento ao Leitor) CONTATO Cartas 0 E-Mails .................................................................... 10 Telefonemas
Site
WhatsApp.............................................................. 19 Total 74 SOLICITAÇÕES Assinaturas 24 Alterações de Cadastro .................................... 16 Outras 104 Total ....................................................... 144 Dados referentes ao período do mês de Fevereiro/2024 30 36 47 20 34 48 54
5
40

Se o trabalho é duro, a tecnologia é
PRO
Organizadores Modulares Smart System





Acesso por acionamento eletrônico, através de cartão Solicite
nas

+ Segurança
Organizadores modulares com trancas eletrônicas
+ Controle
Possibilidade de gerenciar os perfi s de acesso conforme usuário
redes sociais /tramontinapro
visita técnica em: modulares.gar@tramontina.com Saiba mais
6
OFICINAS CHEIAS APESAR DOS FERIADOS
As oficinas continuam movimentadas, mas o feriado de Carnaval freou as ações do mês de fevereiro. Em um ano onde a estabilidade parece predominante, quem investir em estratégias de alto impacto, terá vantagem competitiva. Confira!
Átila Paulino
IMÉDIA DE PASSAGENS: 123 CARROS POR MÊS MERCADO
niciamos o terceiro relatório PULSO DO AFTERMARKET de 2024 consolidando o movimento das oficinas no mês de fevereiro de 2024.
Alguns economistas apostam que o ano de 2024 será um ano flat para economia nacional. O último boletim “FOCUS” divulgado pelo Banco Central ouviu mais de 100 instituições financeiras e a estimativa de crescimento para este ano subiu de 1,75% para 1,77%.
Outra análise está relacionada ao comportamento da inflação, os analistas financeiros baixaram a expectativa para 2024, ou seja, um recuo de 3,8% para 3,76%.
Outras estimativas, dólar estável em R$ 4,93 até o final de 2024, balança comercial estável em US$81 BI de superávit em 2024 e SELIC, que atualmente está em 11,25% projetam até o fechamento de 2024 o juro básico em 9%.
Diante destes indicadores e projeções para este ano analisamos o comportamento das oficinas mecânicas nas primeiras 9 semanas do ano e a perspectiva indica um ano
Acumulado de 01 de janeiro a 02 de Março de 2024: -2,65%
sem muitos altos e baixos para o Aftermarket.
Nos últimos 4 anos o crescimento foi de 46% e para 2024 projetamos um crescimento na casa de 1 dígito.
No último dia 08/03 todo Grupo Oficina Brasil saiu a campo para visitar nossos amigos reparadores, o que chamamos de DIAR R (REPARADOR), ao todo foram 20 oficinas visitadas. Um exercício desta natureza é bastante enriquecedor, pois podemos entender com profundidade o que está acontecendo nas oficinas
mecânicas.
De maneira resumida as oficinas estão abarrotadas de carros, a dificuldade de encontrar peça é algo que existe, mas não foi unânime entre as oficinas, mas a falta de mão de obra é uma dor latente, em geral as oficinas estão buscando maneiras de aumentar sua produtividade, mas o desafio está na qualificação dos profissionais, o que gera um gargalo entre demanda e produtividade.
O último relatório do PULSO DO AFTERMARKET registrou que

o movimento acumulado das oficinas fechou com queda 2,65%. Praticamente metade desta queda foi registrada na semana do dia 11/02 a 17/02, semana do feriado de Carnaval. Podemos explicar este começo não muito aquecido, com base no último quadrimestre de 2023, mas os outros indicadores que evidenciamos no início desta matéria apontam 2024 um ano equilibrado, sem altos e baixos como foram os últimos 3 anos.
É neste ambiente equilibrado que entender mais
sobre a base geradora da demanda é fundamental. Quando todos os ponteiros indicam ser um ano horizontal quem fizer algo de alto impacto, envolvendo inteligência de dados, com ações de cunho emocional e capacitação, junto às oficinas mecânicas, sai na frente dos demais.
Caso a sua marca queira sair na frente dos demais os profissionais da CINAU estão totalmente à disposição para um bate-papo, pois o segundo é o primeiro dos últimos.


- 28,58% - 4,18% - 3,68% - 13,82% - 6,14% - 5,80% -45,17% -14,99% -15,68% -50,00% -40 00% -30,00% -20,00% -10 00% 0 00% 10,00% 20,00% 01/01 a 06/01 08/01 a 13/01 15/01 a 20/01 22/01 a 27/01 29/01 a 03/02 05/02 a 10/02 11/02 a 17/02 19/02 a 24/02 26/02 a 02/03 MOVIMENTO REAL MÉDIA HISTÓRICA
2024 • oficinabrasil.com.br
Março
Quem entende tudo de caminhão não pega a estrada sem ele.


Gates destaca que cresce dois dígitos no Mercado de Reposição
Vinte anos de paixão por carros: A história de Keli Osako, Diretora de Vendas da Gates, que nos conta sobre sua trajetória, a visão da empresa no aftermarket.
Wellyson Reis
Conte um pouco de sua trajetória profissional até os dias atuais?
Minha história no setor automotivo se iniciou em 2001, há mais de 20 anos, mas eu gostaria antes de falar um pouco sobre minha paixão por vendas e por carros, lógico.
Minha trajetória em vendas começou ainda menina, junto com minha mãe, trabalhando em vários segmentos para completar a renda familiar, e depois fomos para a venda de cachorro-quente, em que trabalhamos por mais de 5 anos. Algum tempo depois, eu entendi que queria mais, e fui em busca de mudanças. Então, entrei para o ramo de venda de móveis, meu 1° emprego registrada, porém, nesse meio tempo, eu sempre estive inserida em oficinais mecânicas e de funilaria de amigos e parentes, adorava mexer nos carros, olhar o que eu podia, cabo de velas, velas, mangueiras. Fiquei 3 anos no ramo e, novamente em busca de crescimento e novos desafios, tive a oportunidade de vir para o mercado de reposição automotiva como promotora de vendas para atender os varejos e mecânicos e, daí em diante, não sai mais desse mercado. Sem dúvida, minha experiência como promotora foi primordial para entender o mercado de reposição e toda cadeia, a importância do distribuidor, varejo e os mecânicos, uma escola não apenas profissional, mas de vida.
Tive passagens em grandes e pequenos fabricantes, passei
pela distribuição e pelo ramo de acessórios, mas meu sonho sempre foi voltar a trabalhar em uma grande indústria.
Em 2011 tive a oportunidade de ingressar na Gates, e aqui estou até hoje, muito feliz, realizada, com uma equipe incrivelmente dedicada.
Qual é a perspectiva da Gates para o futuro da empresa nos próximos anos? Como você descreveria a visão estratégica da Gates?
Somos uma empresa sempre atenta aos avanços tecnológicos e tendências de todos os mercados em que atuamos. Trabalhamos muito a ciência dos materiais para aprimorar nossas linhas e nos anteciparmos às necessidades do mercado. É com essa visão que a Gates vem crescendo ano após ano na reposição automotiva, prezando pela manutenção de qualidade.
Quais são os objetivos centrais de vendas e marketing da empresa para o atual ano?

Além de reforçar nossa presença nas linhas que atuamos e já reconhecidas nacionalmente, temos alguns lançamentos e extensões previstas para este ano, sempre buscando atender da melhor forma a frota que temos aqui no Brasil.
Como a Gates está se adap -
tando às últimas tendências e novidades no setor automotivo?
Como comentei, a Gates está sempre atenta às tendências do setor. A nossa participação no mercado de equipamento original nos permite estar próximos aos avanços tecnológicos que as montadoras trazem, e esta-
mos sempre estudando a frota circulante para trazer produtos alinhados com a necessidade do nosso mercado.
Qual é a visão da Gates em relação ao processo de eletrificação dos carros no Brasil?
A Gates está preparada para atender as novas demandas dos carros elétricos, já temos al-
guns produtos voltados para o sistema de arrefecimento desse mercado, por exemplo, como a bomba d´água elétrica. Temos uma equipe global focada nesse segmento, então temos muita troca de conhecimento com o time de desenvolvimento e de vendas em mercados em que a frota de carros elétricos já é maior. À medida que tivermos um aumento dos carros elétricos no Brasil, estaremos prontos para atender essa demanda aqui também.
Quais são as principais oportunidades e desafios que você identifica para a Gates no cenário atual do mercado de reposição?
Entendo que todo desafio é também uma oportunidade para melhorarmos de alguma forma. Enfrentamos diversos desafios durante a pandemia que fizeram que revisássemos processos internos e que geraram melhorias que refletem até hoje. Estar sempre à frente das necessidades do mercado, garantir que a gente tenha o portfólio completo e fazer garantir que toda nossa cadeia tenha o melhor atendimento possível são desafios que por si só fazem com que a gente busque sempre melhorar e se desenvolver.
De que forma a Gates está integrando inovação e tecnologia em seus produtos e estratégias de marketing?
Marketing, produto e vendas andam totalmente integrados dentro da empresa. Assim como buscamos melhoria nos desenvolvimentos de produtos, em garantir a qualidade para a reposição, o nosso time de marketing estuda maneiras de nos comunicarmos de forma cada vez mais
ENTREVISTA 8 Março 2024 • oficinabrasil.com.br ENTREVISTA
efetiva com nossos clientes.
Nossas inovações vão desde o desenvolvimento dos materiais até a forma com a qual disseminamos nossa informação.
Existem planos para o desenvolvimento de produtos ou serviços inovadores nos próximos anos?
Sim, com certeza. Como falei, estamos sempre atentos às mudanças do mercado e antecipando as necessidades futuras. Não posso abrir nosso planejamento, mas a inovação está no DNA da Gates.
Considerando o aumento significativo na variedade de marcas e modelos de veículos, como a Gates lida com essa diversidade na frota circulante e como isso influencia o desenvolvimento do portfólio da empresa?
O desenvolvimento do portfólio está totalmente voltado para a frota circulante. Nossa equipe está sempre de olho nas mudanças e oportunidades que temos de acordo com a frota brasileira. É um estudo que analisa onde estão as frotas, quais estados, características e necessidades dos clientes. É com base nisso que temos lançamentos de novos códigos praticamente toda semana.
Há uma percepção de que a Gates concentra seu foco nas oficinas mecânicas, considerando-as o “último elo” na cadeia de reposição. Isso é uma decisão estratégica e qual a importância atribuída aos reparadores?
Nós prezamos pelo atendimento de qualidade para todo nosso canal de distribuição, na verdade. Entre supervisores de venda, representantes e equipe técnica, temos em torno de 50 pessoas prontas para atender todos nossos clientes. O reparador é sim um ponto essencial na nossa cadeia, pois é ele que aplica nosso produto e que pode atestar a qualidade dos nossos produtos. Levar informação e obter informação dos aplicadores diariamente nos torna mais
fortes, pois é a voz do mercado, é o que faz nossa fábrica rodar 24 horas por dia em três turnos, precisamos e estamos presentes sempre.
A Gates apresentou recentemente sua nova plataforma de catálogo on-line para a linha leve. Qual foi o principal objetivo por trás do desenvolvimento e implementação da plataforma Navigates no Brasil, e como a empresa espera que ela beneficie os reparadores e usuários finais?
O Navigates é uma plataforma própria da Gates, à nível glo -
var em tudo que faz e está pronta a apoiar o mercado nessas transições. Depois do período de adaptação, estamos percebendo que o mercado já está entendendo as vantagens de usar o Navigates. Vale lembrar que qualquer dúvida, nosso 0800 e nossa equipe de vendas estão prontos para ajudar.
Pode compartilhar alguns insights sobre como o NaviGates tem impactado positivamente a eficiência e a precisão do trabalho dos reparadores, considerando as funcionalidades específicas, como a criação
tálogo sempre atualizado, com as informações corretas para o aplicador.
Em 2023, o movimento das oficinas cresceu 13,78%, segundo o PULSO DO AFTERMARKET. Como a Gates se saiu neste período?
Não posso abrir os números, mas a Gates cresce ano após ano, aumentando nossa participação de mercado, chegando a porcentagens de dois dígitos de crescimento.
Quais são as estratégias de vendas principais que a Gates está adotando para aumentar

bal, criada para facilitar a busca pelos nossos produtos, trazendo além das informações de aplicação todos os materiais de marketing e informativos técnicos. A busca do Navigates é inteligente e rápida, o reparador consegue gerar seu próprio catálogo com os veículos que mais atende na sua oficina, além de muitas outras funcionalidades.
Como você avalia a receptividade inicial dos reparadores brasileiros em relação ao Navigates, desde o seu lançamento em outubro de 2023?
Sabemos que tudo que é novo pode gerar um estranhamento. A Gates se propõe a ino -
de catálogos personalizados e o histórico de pesquisa armazenado automaticamente?
Ficou muito mais fácil para o aplicador fazer a busca por uma peça, seja pelo código Gates, código original ou pelo veículo – é só começar a digitar no campo de busca que o Navigates automaticamente mostra as peças disponíveis no nosso portfólio. Além disso, o reparador encontrará guias de instalação e diagramas de posicionamento que auxiliam na montagem dos sistemas e manutenção dos veículos. A Gates tem um time focado em analisar as aplicações do marcado e manter o ca-
fabricação de nossos produtos, além de ações sociais feitas em todos os locais em que a Gates atua. A ciência dos materiais da Gates preza pela sustentabilidade dos nossos produtos também na aplicação, trazendo melhorias no consumo de energia e emissão de CO2. Questões de diversidade e equidade também são trabalhadas diariamente, já temos mais mulheres em cargos de liderança, como eu, por exemplo.
Quais são os diferenciais dos produtos e serviços da Gates em relação aos concorrentes, e como esses diferenciais são percebidos pelos reparadores?
Nossos diferenciais estão na construção dos nossos produtos, nas tecnologias que aplicamos, nos nossos estudos de ciência dos materiais, nos kits que oferecemos, garantindo uma manutenção completa dos sistemas de sincronismo e acessórios, além de uma equipe de vendas e equipe técnica prontas para atender os reparadores no Brasil todo.
Este é o seu espaço para transmitir uma mensagem às 53 mil oficinas que recebem nossa MALA DIRETA. Fique à vontade para compartilhar sua mensagem.
sua participação de mercado?
Além de um portfólio completo de correias, mangueiras, tensionadores e bomba d’água, temos um time extremamente qualificado, pronto para atender toda nossa cadeia de distribuição. Buscamos garantir não só que nossos produtos cheguem na ponta, como que o reparador tenha todo o suporte necessário, incluindo treinamentos feitos pelo país inteiro.
Como a Gates está incorporando as práticas de ESG (ambientais, sociais e de governança) em suas operações?
Nossas fábricas são incorporadas no desenvolvimento e
Gostaria primeiramente de agradecer a oportunidade de falar da Gates para essa audiência tão qualificada e ressaltar aqui, mais uma vez, a importância dos reparadores, que estão no dia a dia da aplicação, para a empresa aqui no Brasil. Nós queremos nos aproximar cada vez mais do público reparador, com treinamentos, com conteúdo nas redes sociais, nos eventos, no nosso 0800 que está sempre à disposição para atendê-los e ouvi-los. E desejar que o ano de 2024 seja frutífero para todos aqueles que atuam no aftermarket automotivo. A expectativa é que seja um ano de crescimento, de muito trabalho e de novidades.
2024 • oficinabrasil.com.br
9 Março
ENTREVISTA
DIA R OFICINA BRASIL!

















O Jornal Oficina Brasil celebrou com orgulho a segunda edição do evento "Dia R (Dia do Reparador)", uma iniciativa dedicada a fortalecer os laços com os reparadores automotivos e compreender melhor suas necessidades. No dia 08 de março, nossa equipe visitou 20 oficinas mecânicas parceiras, mergulhando em experiências enriquecedoras e aprendendo diretamente com os profissionais que são a essência do nosso setor. Ao ouvir suas histórias, desafios e aspirações, reafirmamos nosso compromisso em desenvolver produtos, soluções e suporte que atendam às suas demandas, fortalecendo assim a ligação entre a indústria automotiva e os reparadores brasileiros.








Ninguém tem tanto conteúdo [pro] quanto a ZF.

Amortecedor traseiro BMW
Giro de estoque
Introdução a logística



Mais de 5 milhões de views.
Mais de 40 mil usuários cadastrados.
Com a plataforma [pro]Amigo, você aprofunda os conhecimentos em mecânica, aprende como vender mais e melhor e ainda conhece mais sobre logística. Tudo pra fazer a sua oficina ser

Mais de 100 aulas gratuitas.



Acompanhe nossas redes sociais
190.000 certificados emitidos.
AUDAZ / ZF
Fiat apresenta Titano, sua nova picape, com uma receita simples que pode dar muito certo


Há quase 50 anos no Brasil, a Fiat começa hoje mais um capítulo da sua história. Com ampla tradição em picapes, a marca promete movimentar esse mercado novamente, desta vez com o lançamento da nova Fiat Titano. O modelo chega para completar o portfólio de picapes da marca, expandir a participação no mercado e, ainda, colocar a Fiat em um novo segmento: o de D-picapes. Para isso, a Titano conta com muita robustez, tecnologia, design atraente e o maior volume de caçamba da categoria.
Atualmente é impossível falar de picapes sem citar a Fiat no mercado nacional. A marca mantém a liderança desse segmento há 20 anos. Atualmente, ela possui os dois modelos mais vendidos da categoria,
com a Fiat Strada, que também é o veículo mais comercializado do Brasil há três anos, e a Fiat Toro, que estreou o conceito de Sport Utility Pick-up (SUP) e lidera em seu segmento desde o seu lançamento em 2016.
De um projeto global da Stellantis, nasceu a Titano, uma picape com o DNA da Fiat e com os elementos fundamentais das D-Picapes. Para adaptação ao mercado brasileiro, ela recebeu novas suspensões, coxins de cabine, rodas, bancos e calibrações específicas que garantem mais conforto sem perda da capacidade off-road, além de maior distância do solo e aderência. Além disso, o novo modelo da Fiat foi testado em diferentes pavimentos e condições de temperaturas, justamente para colocar sua durabilidade à toda prova nos variados terrenos e climas brasileiros.
O nome da nova picape foi inspirado na entidade da mitologia grega que enfrenta Zeus e os demais deuses do Olimpo
O nome tem também vínculo com o metal titânio, que possui alta resistência e durabilidade. Tudo isso faz referência à robustez que a picape possui e à sua capacidade de enfrentar qualquer tipo de terreno, seja em estradas desafiadoras ou nos grandes centros.
DESIGN
Personalidade. Essa é a palavra que pode definir o visual
da Titano. Com um design único e robusto, a grandiosidade da picape de cabine dupla pode ser vista logo de cara. Afinal, a nova Fiat Titano tem 5.330 mm de comprimento, 2.221 mm de largura (com espelhos), 1.898 mm de altura (com barras longitudinais) e 3.180 mm de distância entre-eixos.
E não para por aí. Com atributos de um verdadeiro 4x4, a picape possui 235 mm de distância do solo, 29° de ângulo de entrada e 27° de ângulo de saída. Outro destaque é a caçamba: com 1.630 mm de comprimento, 1.925 mm de largura e 500 mm de altura, ela possui o maior volume da categoria, com capacidade de 1.314 litros (sem protetor de caçamba), além de ser equipada com santo antônio, protetor e capota marítima.
A Titano conta ainda com rodas de liga leve de até 18”, que além de darem um ar mais
robusto à picape, possuem grande funcionalidade na utilização off-road e no transporte de cargas mais pesadas.
A picape possui capacidade de carga de 1.020 kg e 3.500 kg de reboque
TECNOLOGIA E SEGURANÇA
A Nova Fiat Titano vem bem equipada em relação à tecnologia. Tem central multimídia de 10” que pode ser personalizada e navegação embarcada TomTom, que facilita o acesso às várias configurações do carro, além de contar com Apple Carplay™ e Android Auto™ para conexão com o
LANÇAMENTO 12 Março 2024 • oficinabrasil.com.br
Kaic Sales
Fotos: Divulgação


celular. Possui ainda cluster com tela digital 4.2” colorida, ar-condicionado digital dual zone e Keyless Entry’n Go (chave presencial com partida por botão). Além disso, traz sistema de alerta de posição do volante, que avisa e orienta o motorista para alinhar a direção antes de sair com o carro, útil para evitar pequenas colisões ao sair de vagas.
A câmera 360° off-road é outro importante diferencial. Além de auxiliar o motorista na hora de estacionar, é ativada automaticamente quando obstáculos são detectados durante a direção. Tudo isso graças às quatro câmeras distribuídas no exterior do veículo, que garantem que a picape esteja pronta para enfrentar qualquer terreno. Vale ressaltar que ela é a única do seu segmento a possuir esse recurso.
O modelo conta com seis airbags, sete alças de segurança e recursos que auxiliam

para uma direção mais segura. Além disso, traz alerta de saída de faixa, que, por meio de uma câmera, reconhece linhas contínuas ou descontínuas, analisa a imagem e aciona um alerta visual e sonoro em caso de desvio de direção. Outra funcionalidade é o Hill Descent Control (HDC), assistente para descidas que permite um controle perfeito e seguro da Titano e da sua trajetória em declives acentuados. O sistema permite a descida do veículo em baixa velocidade, proporcionando mais controle e segurança.
PERFORMANCE
Muito robusta, a Titano possui ótima performance off-road e está pronta para encarar qualquer desafio. Para otimizar a tração em qualquer condição de aderência e carga, a picape conta com uma verdadeira caixa de transferência e bloqueio

manual do diferencial traseiro. É possível selecionar três modos de tração: 2H (2 High Speed), em que a tração fica 100% nas rodas traseiras; 4H (4 High Speed), utilizado quando o veículo está em terrenos desafiadores; e 4H (4 Low Speed), ideal para quando é necessário maior torque, principalmente em condições extremas de off-road. Tudo isso impulsionado pelo motor 2.2l Turbodiesel de 180 cv e 40,8 kgfm (37,7 kgfm na versão manual).
O motor 2.2 BlueHDi foi escolhido pela Stellantis devido à sua aplicação de sucesso nas vans e furgões Peugeot Expert e Citroën Jumper, que também são fabricados no Uruguai.
O motor 2.2 turbodiesel importado da França é o mesmo utilizado na Fiat Ducato
VERSÕES E PREÇO
As três versões da nova Fiat Titano (Endurance, Volcano e Ranch) possuem cabine dupla e contam com o motor 2.2l Turbodiesel e tração 4x4, além de uma ampla lista de itens de série.
• Fiat Titano Endurance –R$ 219.990,00
• Fiat Titano Volcano – R$ 239.990,00
• Fiat Titano Ranch – R$ 259.990,00
A nova Fiat Titano conta também com manutenção competitiva, de forma a proporcionar tranquilidade para os clientes. Sua cesta de peças é a mais competitiva: tem valor 32% menor que a média dos principais concorrentes. Para completar, a Titano entra para a história como o primeiro modelo da Fiat a oferecer cinco anos de garantia de fábrica.

Março 2024 • oficinabrasil.com.br LANÇAMENTO 13
Megane E-Tech, o novo modelo da Renault 100% elétrico visita as oficinas
Carregado de tecnologia e modernidade, levamos para os nossos reparadores conhecer o modelo que segundo a Renault reafirma a continuidade da sua história e o sucesso do nome Megane


Desde seu lançamento em 1995, o Renault Megane tem sido uma figura proeminente no cenário automotivo, combinando design inovador, tecnologia avançada e desempenho confiável. Com mais de duas décadas de história, o Megane evoluiu constantemente, mantendo-se como um ícone da marca francesa Renault.
A meta estava definida, e a Renault estava determinada a conquistar o mercado de carros compactos.
Seu objetivo era claro: criar um veículo que combinasse estilo, praticidade e desempenho em um pacote acessível
O Renault Megane surgiu como uma aposta ambiciosa da Renault para conquistar o mercado de carros compactos. Seu lançamento na época foi marcado pela introdução de características revolucionárias, incluindo um design arrojado e aerodinâmico, mas o Megane não era apenas um rosto bonito; cabine espaçosa e confortável rapidamente conquis-


taram os corações dos consumidores europeus.
Ao longo dos anos, o Megane passou por várias alterações, cada uma trazendo novas inovações e aprimoramentos. Desde sistemas avançados de segurança até tecnologias de economia de combustível, a Renault tem continuamente atualizado o Megane para atender às demandas em constante mudança do mercado automotivo.
Uma das mudanças mais notáveis ocorreu em 2002, quando o Megane ganhou destaque com a introdução do modelo de segunda geração, apresentando um design mais ousado e além do estilo aprimorado, a Renault também

priorizou a segurança, introduzindo inovações como airbags de cortina e controle eletrônico de estabilidade.
Em 2008, a terceira geração do Megane trouxe consigo avanços significativos em eficiência de combustível e redução de emissões, refletindo o compromisso da Renault com a sustentabilidade, apostando em uma gama de motores mais eficientes.
Atualmente, o Renault Megane, nos mercados onde foi comercializado sem interrupções, como por exemplo na Europa, continua a ser uma escolha popular entre os consumidores que buscam um equilíbrio entre estilo, desempenho e praticidade. Com sua quarta geração lançada em 2016,
o Megane incorpora as mais recentes inovações em tecnologia automotiva, incluindo sistemas de assistência ao motorista e conectividade avançada.
Além disso, dessa vez a Renault expandiu a linha Megane para incluir variantes elétricas e híbridas, como parte de sua estratégia para se adaptar às crescentes preocupações com o meio ambiente e às demandas por veículos mais sustentáveis.
Ao longo de sua história, a marca conquistou uma reputação de confiabilidade, conforto e estilo distintivo. Desde sua estreia até os dias de hoje, o Megane tem sido um símbolo duradouro da inovação automotiva francesa, demonstrando a capacidade da Renault de se adaptar e evoluir em um mercado altamente competitivo.
À medida que a indústria automotiva continua a avançar em direção a um futuro de mobilidade sustentável e conectada, o Re-
nault Megane está bem-posicionado para continuar sua jornada de sucesso, mantendo-se na vanguarda da inovação e do design automotivo.
Com o novo Megane E-Tech 100% elétrico, a Renault reafirma a continuidade da sua história e o sucesso do nome Megane. Inscreve o nome na modernidade e no futuro e irá perdurar ao longo deste. Por tudo isto, o Megane E-Tech 100% Elétrico só se podia chamar… Megane!
UM NOVO MEGANE, UM NOVO COMEÇO
Com a chegada do Megane E-Tech 100% elétrico, a Renault abriu um novo capítulo na mobilidade elétrica, baseando-se em seus mais de dez anos de expertise no desenvolvimento, produção, venda e manutenção de veículos elétricos. O Megane E-Tech se beneficia de uma plataforma inédita voltada a veículos elétricos, a CMF-EV, que une o melhor do design, performance e tecnologia num produto único e refinado.
“O Megane E-Tech é o primeiro veículo a ser comercializado da fase Renovation aqui no Brasil, que é a segunda fase do plano estratégico mundial Renaulution. É o primeiro veículo que chega com a nova identidade da Renault, refletindo o novo posicionamento da marca no mundo e no Brasil. Com a chegada do Megane E-Tech nós ampliamos a gama Renault E-Tech no país. Nós acreditamos que o E-Tech conecta inovação e tecnologia a um mundo mais sustentável e esta é a nossa visão de futuro na Renault do Brasil”, explica Ricardo Gondo, presidente da Renault do Brasil.
Com o Megane E-Tech, a

AVALIAÇÃO DO REPARADOR 14 Março 2024 • oficinabrasil.com.br
Kaic Sales kaic.sales@oficinabrasil.com.br



Renault avança no seu plano de eletrificação, atuando em um segmento inédito em sua história no Brasil, visando atender ao cliente que busca tecnologia, sofisticação e modernidade. O perfil desse cliente se define nos chamados early adopters, que buscam alta tecnologia e o que há de mais moderno em design, além de sofisticação e soluções inovadoras para os desafios de uma mobilidade sustentável.
O Megane E-Tech é sucesso na Europa com mais de 60 mil emplacamentos e o mercado brasileiro BEV vem registrando crescimento contínuo. Na comparação do primeiro semestre de 2023 com o mesmo período de 2021, o peso desse segmento já é quatro vezes maior.
No Brasil, a Renault comercializa veículos elétricos desde 2013 em projetos de mobilidade em parceria com empresas e, desde 2018, vendidos para o cliente final.
A Renault marca um novo começo com a decisão estratégica de fabricar o Novo Megane E-Tech Electric na planta de Douai, França, no coração do ElectriCity, o novo polo industrial elétrico de referência na Europa. Com uma ambição de 400.000 veículos por ano, o Renault ElectriCity será

elevado. O motor do Megane E-Tech 100% elétrico é totalmente novo. Ele foi desenvolvido pela Aliança, sendo utilizado por seus diferentes parceiros e produzido em duas plantas: no Japão para a Nissan e em Cléon, na França, para a Renault.
em breve o centro de produção de veículos elétricos mais importante e competitivo da Europa.
A localização ideal na região de Hauts-de-France permite que ele esteja mais próximo da demanda.
A história fala por si só, um modelo que faz parte da gama há 26 anos, com quatro gerações.
O Novo Megane E-TECH presta uma homenagem a este legado, com seu design e versatilidade. Ele mantém e otimiza o DNA que fez de cada geração do Megane uma referência no segmento: prazer de dirigir, conforto, tranquilidade, espaço interno e volume do porta-malas.
Com o novo modelo a montadora demonstra que está dando continuidade à história de sucesso que o nome Megane carrega, inserindo este nome na modernidade e no futuro. Seria lógico dar este nome ao modelo. E é por meio dele que este nome vai ficar na história.
MOTOR Com o motor que oferece 220 cv de potência e 30,6 kgfm de torque, além dos quatro níveis de frenagem regenerativa, o Megane E-Tech eleva o prazer da motorização elétrica ao patamar mais
Há dez anos, a Renault utiliza o motor síncrono como rotor bobinado (Conhecido mais especificamente como motor síncrono eletricamente excitado EESM), e tanto o Renault Group como a Aliança continuarão apostando nesta tecnologia no futuro. Possui melhor potência em comparação com motores de ímã permanente e não requer metais de terras raras, reduzindo assim o impacto ambiental e o custo da produção em larga escala.
Motor compacto, pesando apenas 145 quilos (incluindo a transmissão)
Graças ao design otimizado temo uma redução de 10% no peso em comparação com a motorização utilizada atualmente no ZOE, apesar de um aumento pronunciado na potência e no torque.
Ele oferece todo o prazer da condução elétrica, como aceleração instantânea, tanto dinâmica como linear (sem solavancos), permitindo que o Novo Megane E-Tech passe de 0 a 100 km/h em apenas 7,4 segundos.
BATERIA
Assim como o grupo motopropulsor, o Novo Megane E-TECH conta com uma bateria totalmente nova de 395 quilos, cujo projeto foi feito para se integrar perfeitamente à plataforma CMF-EV. Esta é a bateria mais fina do mercado, pois sua altura é limitada a 110 mm (para 1.960 mm de comprimento e 1.450 mm de largura), ou seja, 40% a menos que a da bateria do ZOE por exemplo. Ela contribui diretamente para limitar a altura do veículo a 1,50 m, beneficiando a aerodinâmica e a eficiência.
O Megane E-Tech tem uma autonomia de até 495 km no uso urbano e 463 km no rodoviário, segundo a norma SAE J1634, utilizada pelo Inmetro. No uso misto, a autonomia é de 481 km na SAE J1634 e 337 km no PBEV (Programa Brasileiro de Etiquetagem Veicular). O valor do PBEV é calculado com uma redução de 30% na autonomia de uso misto da norma SAE J1634.
Bateria fina de 60 KWH proporciona autonomia de até 495 KM
Para chegar a um tamanho tão compacto, as equipes de engenharia se basearam em uma nova versão da química das baterias de íons de lítio com tecnologia NMC (sigla de “Níquel, Manganês, Cobalto”) da LG, que têm
mais níquel e menos cobalto, beneficiando a densidade energética e atingindo 600 Wh/l – um nível 20% superior ao da bateria do ZOE. As equipes também utilizaram – pela primeira vez no Renault Group – um novo sistema de resfriamento líquido. Localizado na parte inferior do módulo da bateria, o sistema alia eficiência e compactação, graças aos tubos de alumínio extrudado. Com apenas 18 mm, ele contribui para uma melhor integração da bateria na plataforma, beneficiando o design e o espaço interno.
A bateria de 60 kWh é composta de 12 módulos com 24 células cada, distribuídos em duas camadas, elas contam com uma garantia de 8 anos. Durante este período, elas são substituídas gratuitamente caso sofram uma deterioração que resulte em um nível inferior a 70% de sua capacidade nominal.
A versatilidade é potencializada pelas várias soluções de recarga, incluindo 130 kW na estrada e 22 kW, amplamente disponível nas cidades. Todas são otimizadas para uma eficiência máxima.
Assim, o novo Megane é compatível com todas as infraestruturas de recarga em corrente alternada (AC): desde uma tomada doméstica (10A/2,3 kW monofásico) até os terminais públicos, que permitem recuperar até 160 km em 1 hora (32A/22 kW trifásico).
Graças às tecnologias disruptivas e as baterias com maior capacidade, a plataforma CMF-EV permite aumentar a eficiência energética e a autonomia de um carro elétrico, reduzindo o tempo de recarga. A condução dinâmica e prazerosa é potencializada pelo chassi e o sistema de direção que foram retrabalhados, bem como o centro de gravidade mais baixo devido à instalação das baterias sob o assoalho.
Mais de 300 patentes foram registradas para a plataforma CMF-EV e o Megane E-Tech 100% elétrico. Estas patentes protegem várias inovações relaciona-
Março 2024 • oficinabrasil.com.br
16
AVALIAÇÃO DO REPARADOR



das ao sistema propulsor, gestão térmica, arquitetura e acústica. O resultado é fruto de uma expertise compartilhada entre o Renault Group e seus parceiros da Aliança, a Nissan e a Mitsubishi.
FRENAGEM REGENERATIVA
A bateria pode recuperar energia a cada frenagem. Mas para otimizar a autonomia independentemente do modo de condução, o novo Megane é equipado com um sistema de frenagem regenerativa otimizada.
A frenagem regenerativa é ativada quando a alavanca de marchas está posicionada no modo D, permitindo recuperar a energia cinética da desaceleração (soltando o pé do acelerador) e transformando-a em energia elétrica, que é armazenada na bateria. Assim, é possível melhorar a eficiência e autonomia do veículo, utilizando menos o pedal do freio.

A autonomia do Megane E-Tech 100% elétrico durante o uso foi aumentada tanto no verão como no inverno, em todas as condições de utilização, graças à alta eficiência energética do veículo. Isso foi possível graças às várias possibilidades de recarga disponíveis, mas também por uma gestão otimizada da recuperação da energia e das trocas térmicas, por meio de um novo sistema patenteado, dividido em componentes, como o sistema inteligente de gestão da energia perdida pelas baterias e o motor, que é reutilizada para aquecer a cabine. Isso foi possível graças à introdução de um sistema de resfriamento líquido para as baterias e o motor (óleo refrigerado a água).
Estes recursos de gestão inteligente do resfriamento da bateria e aquecimento da cabine garantem performance, potência e autonomia constantes em qualquer condição climática, garantindo uma longa duração da vida útil da bateria.
Ele otimiza esta função oferecendo quatro níveis de frenagem regenerativa, que são selecionadas por meio de paletas localizadas atrás do volante: do nível 0 (sem frenagem recuperativa) ao nível 3 (recuperação máxima e freio do motor otimizado, para uma condução bastante intuitiva na cidade).

NAS OFICINAS
Dividimos em duas partes as nossas visitas com o Mégane E-Tech, primeiro visitamos a Motor France SP.
Por lá a primeira impressão foi de encanto com o visual do veículo, o nome Megane sempre remete a um grande modelo da marca, todos relembram com saudosismo do modelo.
Na oficina fomos atendidos pelo Fernando Teodoro Araujo, que trabalha com marcas francesas desde 1994 iniciando essa trajetória com a Renault na fábrica em Curitiba e mais tarde em algumas concessionárias de São Paulo.
A oficina Motor France SP, especializada em veículos franceses, atua na reparação mecânica desde 2006 em São Caetano, e após 2012 se mudou para a Zona sul de São Paulo mais precisamente próxima a Av. Ricardo Jafet, na Rua Vigário Albernaz, 31 - Vila Gumercindo.
Fernando é chefe de oficina e proprietário, ele confessa possuir um certo receio em veículos eletrificados e ainda não possui equipamento e treinamentos para sistemas de alta tensão, porém gosta do modelo e acredita que o
pensão.
Tudo isso explica a ótima experiência de condução, pois além do ótimo conforto ao rodar em ruas irregulares absorvendo bem os impactos das rodas, o Megane tem uma ótima dirigibilidade e realiza tranquilamente curvas em altas velocidades sem precisar de muitas correções na direção.
produto já é uma realidade entre os veículos novos.
Fernando e sua equipe no primeiro momento ficaram curioso em conhecer a arquitetura eletrônica do modelo, e logo disponibilizaram um scanner para fazer a leitura do sistema, porém tivemos alguns problemas.
Ao conectar o aparelho de diagnóstico não encontramos o modelo para selecionar, nem mesmo no modo de leitura automática pelo número dos chassis foi possível, Fernando explicou que poderia estar faltando uma atualização do equipamento para esse modelo e que entraria em contato com o fabricante para solucionar isso já para ter esse modelo disponível.
Após isso realizamos uma análise da parte mecânica do modelo já elevando o veículo no elevador.
De início Fernando e a equipe da Motor France SP quiseram verificar a suspensão do veículo, e a surpresa foi muito positiva.
O modelo foi montado com componentes de suspensão bem sólidos e robustos, isso demostra o cuidado da marca com seu produto, equipado com braços auxiliares fortes e barra estabilizadora tanto na dianteira quanto na traseira tivemos a constatação da qualidade do conjunto de sus-
Um fato notado pela equipe da Motor France foi que apesar da parte de baixo da carroceria estar coberta por plásticos de proteção para evitar avarias nas baterias e auxiliar no arrasto aerodinâmico, na traseira possui uma tampa com abertura e acesso às barras de ajuste da geometria de rodas na traseira, isso ajuda muito o reparador em uma manutenção simples como alinhamento do veículo, sem precisar que ele tenha que remover completamente as capas de proteções.
A parte do cofre do motor despertou muita curiosidade dos nossos reparadores, por eles não terem contato frequente com um veículo elétrico, e foi lá que Fernando encontrou uma importante observação, ele notou que os elementos de fixação do motor (coxins) além de parecerem bem resistentes e robustos, possuem amortecimento por meios hidráu-

licos, utilizando compostos de borrachas e algum fluido armazenado no centro, por outro lado como ponto negativo, os componentes ficam fixados no quadro da suspensão não na carroceria com é comum em maioria dos modelos, isso para quem conduz o veículo pode significar muito conforto em relação a transmissão de vibrações do propulsor para o habitáculo, porém para os responsáveis da manutenção pode ser um inconveniente, pois serão mais itens a serem removidos caso seja necessária a substituição de algum componente envolvido,
Março 2024 • oficinabrasil.com.br AVALIAÇÃO DO REPARADOR 17


por outro lado a remoção completa do motor pode ser facilitada dependendo da forma em que o reparador escolher trabalhar.
Na segunda etapa fomos até a cidade de Mauá, na grande São Paulo. Conhecemos a oficina Infinity Tecnologia em Autos, localizada na Rua Luís Tonelotti, número 12, Bairro Guapituba.
Lá, fomos atendidos pelo Rodrigo Pereira Salviato, que também é o proprietário e chefe da equipe técnica. A oficina do Rodrigo tem 14 anos no ramo de reparo de mecânica, e atualmente se destaca pois já realiza serviços em elétricos e híbridos, atendendo por mês diversos veículos com problemas em baterias, conversores, entre outros.
Além da oficina possuir um carregador Wallbox para carregamento de veículos elétricos, Rodrigo inclusive nos mostra uma das suas principais recentes aquisições, trata se de uma ferramenta para equalização de células de baterias, essa ferramenta é essencial para reparo em veículos ele-





trificados, pois sem ele não seria possível nenhum tipo de reparo interno nas baterias de um veículo elétrico de qualquer marca. Isso demonstra o quando algumas oficinas independentes estão investindo e buscando treinamento para atender esse tipo de veículos, Rodrigo nos contou por exemplo que recebe carros de diversas cidades até de outros estados para realizar manutenções na parte de alta tensão, e agora com


A bateria de íons de lítio é amplamente utilizada em carros elétricos, sendo também comum em dispositivos eletrônicos portáteis como telefones celulares e computadores. Ao contrário de outras baterias, elas não sofrem do efeito de memória, permitindo recargas mesmo sem descarregar completamente, o que não compromete seu desempenho. Além disso, essas baterias são mais eficientes e consistentes, o que as torna livres de manutenção.
essa ferramenta ele irá atender ainda mais clientes e até oficinas que quiserem mandar apenas as baterias para reparo e substituição de células.
Falando em bateria a equipe da Infinity Tecnologia revela pontos importantes sobre o acumulador do Mégane E-Tech, mesmo com uma boa capacidade e uma ótima autonomia comparado com outras modelos do mercado, a bateria do nosso veículo revela
ser bem compacta, estando bem localizada na carroceria do veículo, e segundo nossos técnicos ela aparenta possuir fácil remoção e instalação por conta de sua disposição e disposição dos componentes de fixação, além de possuir uma boa proteção em relação aos componentes como as mangueiras e conectores do sistema de refrigeração, que geralmente ficam expostos e suscetíveis a avarias em casos de colisões na parte inferior do veículo.
A bateria do Mégane E-Tech é do tipo íons de lítio
Um dos pontos bem observado por Rodrigo foi a presença de alguns “bojões” para retirada do óleo do motor, sim óleo no motor, mas esse lubrificante tem uma função um pouco diferente dos motores a combustão, pois ao contrário de apenas lubrificar e em consequência realizar a troca de calor, no conjunto propulsor do Megane o óleo tem o principal objetivo de manter o propulsor sempre em uma temperatura ideal, fazendo que o óleo circule em componentes estratégicos para reduzir o calor do rotor e estator, otimizando o trem de força. Para fins de manutenções, não encontramos informações reveladas pela montadora a respeito da necessidade ou prazo para troca de óleo desse sistema.
Comentei com a equipe de Rodrigo que em outra oficina não conseguimos realizar uma leitura do sistema eletrônico por meio do scanner, e eles prontamente buscaram o equipamento deles para tentar realizar uma leitura. Na oficina do Rodrigo o resultado foi diferente, o aparelho de diagnóstico dele conseguiu realizar a leitura do sistema, porém não passamos disso, o sistema libera apenas leitura de valores, existem poucos testes ou ativação de atuadores dentro das possibilidades do scanner.
Março 2024 • oficinabrasil.com.br
DO REPARADOR 18
AVALIAÇÃO









FAÇA DA SUA REFERÊNCIA NESSA ROTA! Presencial e On-line Acompanhe nossas aulas on-line pelo QR CODE! 100% Gratuito Certificado exclusivo Treinamentos técnicos para os profissionais da reparação automotiva
CHEGANDO EM SUA CIDADE! Em breve desbloquearemos a sua nova jornada do conhecimento
Patrocinadores: Apoiadores:
ESTAMOS
Realização:
Ford Escort 1.8 XR3, o primeiro modelo da Autolatina agradava em desempenho
Anderson Nunes
Oprimeiro resultado concreto da Autolatina a ser colocado no mercado, o Escort XR3 despontava em desempenho com a adoção do motor VW AP de 1,8 litro acoplado ao câmbio do Golf alemão.
A Autolatina foi a holding que surgiu a partir da união operacional da Volkswagen e Ford, no Brasil e Argentina, e que perdurou entre os anos de 1987 a 1994. Autolatina foi formalmente anunciada em 1° de julho de 1987. A troca de sinergia entre as duas companhias tinha como meta de diminuir custos de produção e compartilhamento de plataformas, motores e áreas de engenharia.
O primeiro trabalho concreto da Autolatina a ser ofertado ao consumidor foi o Escort equipado com o motor Volkswagen, apresentado em maio de 1989. Com seis anos de mercado, o Escort havia obtido bons números de vendas, figurava até aquele momento como o terceiro veículo mais vendido, porém carecia de um motor à altura do seu projeto. Tal deficiência foi sanada ao incorporar o conjunto motor e câmbio que era importado da Alemanha, onde equipava a linha Golf. Os motores Volkswagen estavam disponíveis para os modelos XR3, XR3 Conversível e Ghia.
O objetivo da Ford com a troca do trem de força era alavancar às vendas do Escort, além de fazer frente ao recém-lançado Chevrolet Kadett, apresentado em abril daquele ano. Com o novo conjunto propulsor, a Ford projetava um aumento de participação do Escort no seu segmento que era de 28 para 37%, isso em números reais era aproximadamente 90 mil unidades

comercializados no ano de 1989.
PROJETO DE 22 MILHÕES DE DÓLARES
Para que o motor Volkswagen pudesse ocupar o cofre do Escort, a Ford investiu um montante de 22 milhões de dólares. O trem de força do Escort XR3 era praticamente o mesmo empregado no Gol GTS, o AP 1,8 S, mas com diferenças em seus periféricos – basicamente, adaptações exigidas devido a posição transversal (longitudinal no Gol). A primeira barreira encontrada pela engenharia da Autolatina foi em relação a posição do filtro de ar – o original não caberia devido ao desenho do capô ser baixo -, a solução foi fixá-lo próximo a caixa de roda e ligá-lo ao carburador por intermédio de uma flange de borracha. Outras mudanças exigidas foram a adoção de um novo coletor de escape, cárter, pescador da bomba de óleo, mangueiras
do sistema de arrefecimento e a ancoragem do compressor do ar-condicionado. Já na parte de fixação do motor/câmbio, os coxins foram redesenhados e ganharam um novo material mais resistente que visava reduzir as vibrações e ruídos.
As melhorias técnicas refletiram-se no comportamento das curvas de potência e torque do motor. A potência máxima, que no Gol GTS acontecia a 5.600 rpm, passou para 5.800 rpm no XR3 1,8 litro. E houve uma melhora no nível de torque: indo de 14,9 para 16 m.kgf, com a vantagem de ocorrer já nos 3.200 rpm (no GTS 3.600 rpm) A potência declarada era de 99 cv. A versão XR3 era oferecida somente com o motor a álcool.
A colocação do conjunto propulsor em posição transversal também envolveu a instalação de uma nova caixa de câmbio oriunda do Golf alemão. Denominado 020M, apresentava cinco marchas sem Overdrive, ou seja, a última
marcha era a de velocidade máxima (cinco marchas reais). Com a mudança do câmbio, foi alterada também a posição de engate da marcha à ré, que agora fica próxima à primeira marcha. Outros atributos do câmbio Volkswagen era adotar engrenagens helicoidais, características que conferiam menos atrito e trocas de marchas mais precisas.
Também foi feito todo um retrabalho na suspensão, para melhorar a estabilidade a barra estilizadora dianteira teve seu diâmetro aumentado para 22 mm e as molas e amortecedores foram recalibrados. Quanto aos freios não houve nenhuma modificação no sistema, pois eles já estavam superdimensionados para o veículo.
Houve um ganho de desempenho do Escort XR3 com o emprego do motor AP 1,8 S, como apontava o primeiro teste feito pela revista Auto Esporte. “O ronco do motor é diferente. A sensação é de um carro extremamente rápido. E não
é só a sensação, o novo XR3 é mesmo rápido e o mais importante, desenvolve velocidade máxima sem esforço. A tração dianteira e o novo câmbio importado ajudam na escalada da velocidade máxima e nas retomadas”. No teste promovido pela publicação, o Escort XR3 1,8 litro atingiu velocidade máxima de 180 km/h e acelerou de 0 a 100 km/ em 10 segundos. Já no interior, o acabamento era o mesmo empregado no Escort XR3 com o motor CHT de 1,6 litro. O revestimento dos bancos e laterais das portas era sempre em tecido cinza. Entre os opcionais estavam o ar-condicionado, vidros e travas elétricas, rádio toca-fitas e o teto-solar. O catálogo de cores era farto, as cores sólidas eram o branco Diamond, preto Dakar, vermelho Rosso e amarelo Citrino. Nas metálicas havia o prata Strato, cinza Executive, cinza Bristol, ouro Colorado, azul Mistral, verde Cassata e azul Matisse. Já os tons perolizados eram o vermelho
DO FUNDO DO BAÚ 20 Março 2024 • oficinabrasil.com.br
No ZF [pro]Tech, sempre tem conhecimento chegando.
Quem faz parte da maior comunidade on-line de oficinas do país sempre tem acesso a conhecimento técnico para ir mais longe. Entre gratuitamente para o ZF [pro]Tech e participe dos treinamentos!

Além dos treinamentos ao longo do ano, você tem:
Treinamentos técnicos exclusivos.
Acesso a eventos especiais e exclusivos ZF.
Materiais informativos do mercado.
Atendimento técnico prioritário na central ZF.
Plataforma de agendamento, conectando você ao seu cliente.
Auxílio nos negócios da oficina e muito mais!
Ficou com alguma dúvida? Entre em contato:
0800 011 1100
(11) 3078-0720
contato@oficinaszfprotech.com.br
AUDAZ / ZF Escaneie agora o QR Code e venha com a gente!
Próximos treinamentos: Arrefecimento On-line Presenciais Injeção Eletrônica Lubrificantes 14/3 23/4 25/6 Câmbio Automático, Automatizado e Manual 21/5 Caixa de Direção Elétrica 26/3 SÃO PAULO SOROCABA




Uma característica única dos veículos da Ford são as plaquetas que identificam o modelo, versão, acabamento e os opcionais, neste caso, o Escort XR3 que ilustra a reportagem conta com todos os itens: ar-condicionado, teto-solar, vidros e travas elétricas e pintura metálica.


Boa ergonomia e a posição de direção correta são os predicados que fizeram a fama do Escort, chama a atenção o rádio toca-fitas original, algo que valoriza o modelo
Mandarino e ouro Mosele.
Entre as novidades estéticas, o Escort XR3 1.8 ganhava novas rodas de liga leve raiadas, o desenho é o mesmo empregado no irmão Sierra Cosworth Internamente não houve mudança no padrão de acabamento do Escort 1.8 XR3, mantendo o mesmo revestimento dos bancos encontrado na versão equipada do motor CHT 1,6 litro
MAIS CONFORTO
A novidade na linha 1990 eram os para-choques pintados na mesma cor da carroceria para a versão esportiva. Já no XR3 Conversível a tão aguarda capota com acionamento eletro-hidráulica passava a estar disponível. Com simples toque no botão localizado no console central, a capota era aberta ou fechada totalmente em dez segundos.
Com a crise do abastecimento do álcool ocorrida no início da virada da década, a Ford passava a oferecer no Escort XR3 a opção do motor a gasolina. Alimentado pelo combustível fóssil, houve uma perda de potência, caindo dos 110 para 97 cv, resultando isso em uma queda na velocidade máxima que agora era de 166 km/h e aceleração até os 100 km/h ficava na casa dos 12,40 segundos. Já o consumo
médio ficava na casa dos 12 km/l.
Já desatualizado em desenho em relação ao modelo europeu, o Escort brasileiro foi alvo de mudanças focadas mais ao conforto dos ocupantes na linha 1991. A principal foi a adoção da regulagem de altura do banco do motorista. Também foram acrescentados à lista desembaçador do vidro traseiro e luzes internas com temporizador, espelhos retrovisores com regulagem elétrica, luz de advertência no painel indicando portas entreabertas, antena elétrica e novo padrão de tecido para revestimentos dos bancos e das portas. O nome da versão passou a ser confeccionado em uma plaqueta de material plástico. As novas normas de emissões de poluentes obrigaram a instalação do catalisador em toda a linha
Na versão XR3 o volante trazia desenho único com apoio para mãos perfurado
Escort 1992, sendo que tal dispositivo reduziu a potência do motor AP 1,8 S para 105 cv no álcool e 95 cv na versão a gasolina. A direção com assistência hidráulica passou a figurar entre os opcionais. Já na aparência as novidades eram as rodas com a face polida e um novo desenho do aerofólio que passava a ter mesma cor da carroceria.
Para o 17 º Salão do Automóvel realizado em outubro de 1992, a Ford apresentava a segunda geração do Escort nacional, correspondente à quarta para os europeus. Para a versão XR3 o tão aguardado motor AP 2000, equipado com injeção eletrônica, o mesmo do Gol GTI, enfim era oferecido. O modelo já teve sua história abordada aqui na seção Do Fundo do Baú.
PRIMEIRA FORNADA
Produzido por período relativamente curto, apenas quatro anos, o Escort 1.8 XR3 e principalmente sua versão conversível,
são hoje modelos que começam a despertar interesse dos colecionadores. Os veículos da primeira safra, ou seja, lançados em 1989, são as versões que possuem um apelo a mais, devido às características únicas como os para-choques sem a pintura e além de trazer aquele valor histórico, já que são os primeiros modelos a exibir de fato, a troca de sinergia entre a Volkswagen e a Ford.
Após muita procura, nós da seção Do Fundo do Baú, localizamos um modelo que literalmente pode se dizer ser da primeira fornada dos Escort XR3 equipados com o motor AP 1,8 S, pois nos cintos de segurança está carimbada a data de 22 maio de 1989. De propriedade do advogado e dono da loja Raros Exemplares, Ricardo Mora Oliveira, da cidade de Sorocaba, cidade do interior de São Paulo, o veículo é um verdadeiro atestado histórico de como foi a união entre a Volkswagen e Ford.
O Ford Escort 1.8 XR3, ano 1989, traz a pintura metálica azul Matisse e exibe no hodômetro 120 mil km originais, foi adquirido em 2022 na cidade de Campinas, interior de São Paulo. Um dos motivos que fizeram o advogado arrematá-lo o era o fato de veículo ter a sua estrutura original e intacta. “O Escort encontrava-se em bom estado de conservação, apenas a pintura tinha desgaste da idade, além necessitar de revisão na mecânica e no ar-condicionado”,
explica Mora.
O passo seguinte foi desmontá-lo, fazer a parte de funilaria com um banho de tinta, revisar a mecânica e higienizar o acabamento. Outro detalhe que chamou a atenção do comerciante é que o XR3 mantinha boa parte de suas peças originais, um pormenor que facilita a restauração e o deixa mais íntegro. No caso do Escort XR3 que ilustra a matéria a tapeçaria, volante e até mesmo na borracha dos pedais detém a sua marca da idade e quilometragem original.
“Eu procuro exemplares que detém bons níveis de originais, principalmente no que diz respeito à parte de acabamento, pois sabemos que é difícil encontrar tecidos, revestimentos para substituição. Não menos importante, foi trazer de volta o adesivo com o nome da versão para a cor vermelha, antes estava na tonalidade preta”, relata.
Embora o processo de restauração tenha sido feito dentro do cronograma, Ricardo Mora explica que algumas peças há dificuldade para se encontrar como os faróis, lanternas originais (usadas) e que sofreram um enorme ágio no mercado virtual. “No caso, em especial, a exemplo, precisei comprar uma lanterna dianteira usada original, pela qual se pede na Internet até R$ 800,00”, diz Mora.

22 Março 2024 • oficinabrasil.com.br DO FUNDO DO BAÚ
Motor VW AP 1,8 litro é o mesmo do Gol GTS, instalado em posição transversal e acoplado ao câmbio do Golf alemão

Fórmula E chega em São Paulo com tecnologia, competição e um olhar para um futuro sustentável
A Fórmula E, categoria de automobilismo totalmente elétrica, desembarcou na cidade, deixando uma marca não apenas no asfalto, mas também na mentalidade dos paulistanos

Acasa das lendas do automobilismo recebeu mais uma corrida no calendário! As ruas de São Paulo abriram alas para os carros elétricos mais velozes do planeta, numa prova super disputada em que a diferença entre os competidores é de milésimos de segundos.
O palco foi um circuito improvisado no Sambódromo do Anhembi (Zona Norte da capital paulista) com 2.933 metros de extensão e 11 curvas.
E os brasileiros não marcaram presença apenas nas arquibancadas. O país foi representado pelo paulista e ex-campeão da categoria Lucas di Grassi e pelo mineiro Sérgio Sette Câmara nesta que foi a segunda prova da categoria realizada no Brasil.
ENERGIZANDO AS RUAS DA METRÓPOLE
São Paulo, uma das cidades mais vibrantes e cosmopolitas do mundo, recebeu um evento esportivo eletrizante, que, além de energizar as ruas da metrópole, impulsionou a consciência ambiental e a inovação tecnológica de seus cidadãos.
As ruas icônicas de São Paulo foram transformadas em um circuito desafiador, onde os pilotos enfrentaram curvas fechadas, retas impressionantes e curvas apertadas. A Fórmula E não é apenas uma corrida: é um teste de habilidade, estratégia e eficiência energética. O traçado urbano trouxe um toque espe -
cial à competição, aproximando os carros elétricos do público e destacando a importância da mobilidade sustentável nas grandes cidades. A escolha de São Paulo como sede da Fórmula E não foi aleatória. Além de ser uma das megacidades mais populosas do mundo, São Paulo enfrenta desafios ambientais significativos, e eventos como esse destacam a crescente conscientização sobre a necessidade de se adotarem práticas sustentáveis. A Fórmula E serve como uma plataforma para promover a mobilidade elétrica e inspirar mudanças positivas na maneira como nos deslocamos.
sistemas de propulsão elétrica, baterias de alta performance e estratégias de gerenciamento de energia. Essas tecnologias não apenas impulsionam os pilotos na pista, mas também têm o potencial de influenciar

o desenvolvimento de veículos elétricos de rua.
TECNOLOGIA E INOVAÇÃO
Por trás dos carros silenciosos e ambientalmente amigáveis da Fórmula E, reside uma impressionante quantidade de inovação tecnológica. As equipes trabalham incansavelmente para aprimorar os
Na última década, a Fórmula E foi pioneira em engenharia de ponta e desenvolveu um formato esportivo para entusiasmar os fãs, oferecendo aos fabricantes um ambiente de teste de tecnologia líder mundial. A 9ª temporada viu o início da era Gen3. De 225 km/h
no Gen1, a velocidade máxima foi para 322 km/h no Gen3, um aumento de 97 km/h, ao mesmo tempo em que a capacidade de regeneração foi aumentada de 100 kW para 600 kW. O carro é uma central elétrica sobre rodas, gerando quase 50% da energia utilizada na corrida durante a prova.
Com o novo Gen3, agora totalmente revelado, a próxima evolução do Campeonato Mundial de Fórmula E da ABB FIA prevê um piloto totalmente elétrico, que seja a interseção de desempenho, eficiência e sustentabilidade.
A seguir, os principais fatos e números por trás do salto geracional promovido pelo Gen3 na Fórmula E:
•O carro de Fórmula E mais rápido até agora, com velocidade máxima superior a 322 km/h/200 mph.
•O carro de corrida de fórmula E mais eficiente de todos os tempos, com quase 50% da energia usada em uma corrida
produzida pela frenagem regenerativa.
•Cerca de 95% de eficiência energética de um motor elétrico que fornece até 350 kW de potência (470 BHP), em comparação com aproximadamente 40% para um motor de combustão interna.
•O primeiro carro de fórmula E com motorização dianteira e traseira. Um novo motor dianteiro acrescenta 250 kW aos 350 kW traseiros, mais do que duplicando a capacidade regenerativa do atual Gen2, para um total de 600 kW.
GERAÇÃO SUSTENTÁVEL
•As baterias GEN3 estão entre as baterias mais avançadas e sustentáveis já fabricadas, consistindo em minerais de origem sustentável, enquanto as células da bateria serão reutilizadas e recicladas no final da vida útil.
•Linho e fibra de carbono reciclados são utilizados na construção de carrocerias pela primeira vez em um carro de fórmula, com fibra de carbono reciclada de carros Gen2 aposentados, reduzindo a quantidade total de fibra de carbono virgem utilizada. Isso reduzirá a pegada de carbono da produção da carroceria Gen3 em mais de 10%. Todos os resíduos de fibra de carbono serão reutilizados para novas aplicações através da adoção de um processo inovador da indústria da aviação.
•Borracha natural e fibras recicladas representarão 26% dos novos pneus Gen3, e todos os pneus serão totalmente reciclados após as corridas
•O Gen3 terá carbono líquido zero. A pegada de carbono
EVENTO 24 Março 2024 • oficinabrasil.com.br
Kaic Sales kaic.sales@oficinabrasil.com.br

do Gen3 foi medida desde a fase de design para informar todas as medidas de redução tomadas para diminuir o impacto ambiental, enquanto todas as emissões inevitáveis serão compensadas como parte do compromisso de zero carbono líquido da Fórmula E.
• Todos os fornecedores, concorrentes e fabricantes Gen3 operarão de acordo com os principais padrões internacionais para reduzir os impactos ambientais da fabricação (ISO 14001), e serão classificados com três estrelas na Acreditação Ambiental da FIA, o mais alto nível de certificação da FIA.
O IMPACTO SOCIOECONÔMICO
DA FÓRMULA E
Além do espetáculo nas ruas, a Fórmula E trouxe consigo uma


ximadamente 415 toneladas de cargas de elevado valor por corrida, incluindo carros de corrida, baterias, unidades de carga, transmissão de equipamentos e equipamentos de marketing e hospitalidade.
série de benefícios socioeconômicos para São Paulo. Desde a criação de empregos temporários até o aumento do turismo, o evento gerou uma onda positiva de atividade econômica na cidade. Além disso, ao destacar São Paulo como um centro global de eventos esportivos e inovação, a Fórmula E ajuda a fortalecer a reputação internacional da metrópole.
Enquanto a poeira baixa após a emocionante corrida da Fórmula E, o legado sustentável perdura. A conscientização sobre a mobilidade elétrica é impulsionada, as tecnologias verdes são refinadas e o compromisso de São Paulo com um futuro mais limpo e sustentável é reforçado. A Fórmula E não é apenas uma corrida: é um catalisador para a mudança, deixando um impacto duradouro nas ruas e na mentalidade desta cidade dinâmica.

LOGÍSTICA MUNDIAL
A DHL e a Fórmula E são parceiras para realizar uma logística verde para a principal categoria de esporte a motor elétrico do mundo.
Usando biocombustíveis para todo o transporte rodoviário e marítimo, a DHL cobrirá os 89.100 quilômetros esperados para essa temporada da Fórmula E, movimentando apro-
“A DHL ajudou a dar vida à Fórmula E e tem sido um parceiro valioso desde então”, diz Matt Scammell, diretor comercial da Fórmula E. “A DHL desempenha um papel crítico na entrega de todos os eventos de corrida em todo o mundo, sendo pioneira em soluções de ponta em eficiência e sustentabilidade, tornando-as perfeitas para o campeonato”. Como pioneira da logística verde, em 2008 a DHL se tornou a primeira empresa de logística a se comprometer com uma meta mensurável de carbono, comprometendo-se a melhorar a eficiência de carbono em 30% (em relação a 2007) até 2021. Esse objetivo foi alcançado quatro anos antes do previsto, em 2016. Em março de 2017, a DHL anunciou o compromisso de atingir zero emissões líquidas até 2050. Em 2021, o Grupo Deutsche Post DHL se comprometeu a investir 7 bilhões de euros em operações limpas e logística neutra para o clima até 2030. Os fundos serão usados, por exemplo, para eletrificar 60% da frota até 2030, colocando mais de 80 mil veículos elétricos nas estradas.
Março 2024 • oficinabrasil.com.br EVENTO 25
AULA 86 – Identificação das falhas relatadas
A sua ficha de recepção deve ter um campo para escrever as falhas identificadas pelo cliente, essa é uma fase importante que vai fazer toda a diferença na entrega final do veículo com as devidas soluções!
 Pedro Luiz Scopino scopino@automecanicascopino.com.br
Pedro Luiz Scopino scopino@automecanicascopino.com.br

Arecepção do cliente é um momento muito importante, primeiro para quebrar a barreira do “gastar” dinheiro na oficina, para vender soluções para os problemas identificados e também os ocultos do veículo. Mas escrever estas reclamações pode trazer soluções simples, e depois de solucionadas, podemos e devemos investir na inspeção de itens na manutenção preventiva. Portanto na sua recepção deve haver, além da boa receptividade, a orientação para escrever e tentar explorar ao máximo o que é percebido pelo cliente ou mesmo pelo motorista do veículo. Ninguém melhor que um condutor que dirige o veículo todos os dias, ou boa parte deles, em uma estrada, no trânsito, em um dia muito frio, em um dia muito quente, em buracos, em lombadas, etc.
NEM SEMPRE O CLIENTE SABE O QUE QUER!
O diagnóstico inicial deve ser seguindo as reclamações relatadas na recepção, sempre comunico ao meu time de mecânicos a primeiro ter certeza da solução da falha reclamada, é o ponto primordial, depois vamos ao check list de manutenção preventiva. Primeiro devemos ter a solução ao o que o cliente percebeu de falhas e identificou na recepção, depois seguimos com a venda honesta de itens realmente necessários na manutenção preventiva.

AS VEZES UM “NHEC NHEC” NO PORTA- MALAS É O QUE MAIS INCOMODA!
E tem que ser escrito na linguagem que o cliente relatou, ou seja, na real percepção dele. Pode ser um “nhec nhec”, um ronco de trem, uma engasgada, um toc toc, uma grilada, uma chiada, um grilo! Enfim, são muitas as formas que o cliente percebe a falha, e na oficina temos que estar atentos a isso. Pode ser que o grilo na traseira do veículo seja um macaco solto no porta-malas, e já pensou, se você examinou este carro, e honestamente, encontra amortecedores traseiros com vazamento e perda de ação, molas traseiras cansadas batendo elo com elo, e batentes estourados. Você faz o orçamento e depois de aprovado, executa o serviço que realmente era necessário. O carro fica ótimo! Mas
ao testar o veículo o tal do grilo continua! Por isso é fundamental descrever a reclamação relatada tal como o cliente passou.
É IMPORTANTE ESCREVER MESMO O QUE O CLIENTE RELATA
E como exemplo, temos dentro do nosso check out de entrega técnica de uma oficina forte um campo a ser preenchido para marcar, que as reclamações relatadas foram inspecionadas e resolvidas. Ou seja, a ficha de recepção é fundamental na entrada, começando os serviços, e no final na saída, para ter a certeza absoluta que, o que o cliente reclamou na sua forma de ver e sentir, foi solucionado. Temos inclusive, dentro da ficha de recepção, um campo para o técnico descrever a solução, ou seja, fica claro ao cliente a solução à sua reclamação relatada.
CONCLUSÃO
Entender o que o cliente precisa não é simples, mesmo porque a grande maioria pouco entende de carros, e essa tendência só vai aumentar. Se hoje perguntar em uma amostra de pessoas jovens, abaixo de 25 anos por exemplo, qual a diferença de um motor 3 cilindros pra um V6, com certeza a maioria não vai saber responder, pois não há interesse. Os carros são basicamente um meio de locomoção do ponto A ao B, e pode ser feito também com motorista de aplicativo. Portanto, saber na recepção, no momento de entrada do carro qual a reclamação em
sua ótica, ou seja, na forma de ver, ouvir ou sentir é essencial e pode fazer uma grande diferença. E isso ajuda muito na satisfação e experiência do cliente com a sua oficina.
Pensem nisso! Mas não se esqueçam, que além de ser mecânico, tem que ser gestor. Transforme a sua empresa em uma oficina forte! Faça a gestão da sua empresa, ela é muito importante e vital para a vida empresarial!
PRÓXIMOS TEMAS
Aula 87 Não use algumas palavras!
Aula 88 A compra de peças
Aula 89 O fornecimento de peças
Abraço a todos e até o próximo mês e $UCE$$O!




Apoio:


Mecânico de Autos Profissional, Bacharel em ADM de Empresas, diretor da Auto Mecânica Scopino, idealizador do movimento Oficina Forte, professor do Umec e da TV Notícias da Oficina VW, integrante GOE e dos Mecânicos Premium, ministra treinamentos e palestras por todo o Brasil. Contrate um professor que tem uma empresa e experiência no setor automotivo.scopino@automecanicascopino. com.br - Instagram: @professorscopino @oficinaforte

• oficinabrasil.com.br
GESTÃO 26 Março 2024


















Turbinas de geometria variável (VGT) aplicadas em motores diesel
Conhecer os tipos e entender o princípio de funcionamento das turbinas de geometria variáveis aplicadas aos motores diesel leves e pesados

Oturbocompressor de geometria variável consiste em um compressor centrífugo e uma turbina dotada de um dispositivo de lâmina móvel capaz de modificar a direção e a seção de passagem de gases de escape direcionados para o rotor da turbina.
Graças a esta solução, é possível manter alta a velocidade dos gases e da turbina mesmo quando o motor funciona em baixas rotações.
Durante as baixas rotações do motor, temos pouco volume de gás de descarga sendo expelido. Como a energia utilizada para girar a turbina provém dos gases de escape, em baixas rotações a turbina gira devagar, o que não proporciona um grande enchimento do compressor.
Neste momento, a central pilota o acionamento do atuador da turbina (Turbo VGT), este restringe a passagem dos gases de escape e esta restrição aumenta a velocidade com que o gás toca a pá da turbina (ganha energia cinética), aumentando assim a rotação da turbina em baixas rotações do motor (baixas cargas), o que resulta em mais ar sendo comprimido pelo compressor e admitido pelo motor, este processo proporciona torque mesmo em baixas cargas e auxilia o condutor em situações como arrancar com o caminhão carregado, subida de serra, ultrapassagens, melhora as retomadas, dentre outras.
Nesta condição, as lâminas


móveis (1) estão na posição máxima fechada, e as seções reduzidas da passagem entre as pás aumentam a velocidade com que os gases de escape atingem o rotor da turbina. Consequentemente, a velocidade da turbina (2) aumenta e, portanto, a pressão de sobrealimentação. Ao aumentar a velocidade de rotação do motor, obtém-se um aumento progressivo na velocidade dos gases de escape. A unidade de controle eletrônico, por meio de um atuador do tipo elétrico ou pneumático, controla a abertura das lâminas móveis (1), orientando-as para que alcancem a posição máxima. Obtém-se assim um aumento nas
seções de passagem, cuja consequência é uma desaceleração do ¬ fluxo de gases de escape que passam pela turbina (2) com velocidades iguais ou inferiores à condição de regime baixo. A unidade de controle do motor regula a orientação das lâminas móveis, podendo regular a pressão em qualquer situação de superalimentação.
TIPOS DE TURBINAS VGT
As turbinas de geometria variável são gerenciadas pela central de controle do motor, que faz a sua gestão por meio de um atuador pneumático ou atuador elétrico.


TURBINAS COM ATUADOR PNEUMÁTICO
O comando pneumático serve para regular a quantidade de ar transmitido pela turbina ao eixo do turbocompressor. Ele é alimentado em depressão pelo circuito de vácuo do motor. Um sensor de posição sobre o comando pneumático permite enviar a informação de posição ao módulo do motor. O sensor indica com precisão a posição exata das aletas móveis da turbina.
O comando pneumático permite mudar a posição do platô de acionamento móvel por meio da biela de comando. A mudança de posição do suporte de acionamento móvel faz pivotar as aletas. A rotação

das aletas relativamente ao seu eixo permite:
• A variação da secção de entrada dos gases de escape na turbina de escape;
• Dirigir com maior precisão os gases de escape na turbina de escape;
LEGENDA IMAGEM 5
g. Tirante de comando das pás móveis da turbina;
k. Prato de engrenagem móvel; m. Aletas móveis; n. Retorno das aletas móveis.
ELETROVÁLVULA DE REGULAGEM DA PRESSÃO DE SOBREALIMENTAÇÃO
1. Eletroválvula; a. Entrada de depressão; b. Saída de depressão; c. Entrada de ar; d. Conector elétrico.
A eletroválvula é do tipo normalmente fechada. Ela per-
Renato França
1
REPARADOR DIESEL 28 Março 2024 • oficinabrasil.com.br
2 3 4 5


mite regular e limitar a depressão de comando na entrada do acionador pneumático da turbina, a partir de vácuo da bomba de vácuo.
O comando da eletroválvula é do tipo RCA (relação cíclica de abertura) e é ligada aos seguintes elementos:
• Pressão atmosférica;
• Depressão fornecida pela bomba de vácuo;
• Acionador pneumático da turbina.
TURBINA VGT COM ATUADOR ELÉTRICO
Turbocompressor de geometria variável (VGT) gerenciado pelo módulo de controle do motor via controle elétrico e atuador.
1 – Motor elétrico com sensor de posição integrado; 2 – Compressor; 3 – Turbina; 4 – Haste da VGT.

Operação:
O sensor (T-MAP) instalado no coletor de admissão mede uma pressão de sobrealimentação em relação ao fluxo de ar que passa pelo coletor.
O T-MAP envia esta informação diretamente para o módulo de controle do motor. Paralelo a esta medição, uma verificação direta da posição do atuador eletrônico é enviada através do sensor de posição interno.
O controle eletrônico do atuador de geometria variável permite maior controle de emissões e otimização do consumo de combustível. Além disso, o tempo de resposta de abertura e fechamento é menor em comparação com o atuador pneumático equivalente.
MOTOR ELÉTRICO COM SENSOR DE POSIÇÃO INTEGRADO – PIN-OUT
1 - Fornecimento de alimentação do atuador de geometria variável;
2 - Terra do atuador de geometria variável;
3 –Massa do sensor de posição;
4 –Sinal do sensor de posição;
5 - Positivo do sensor de posição.
Esta solução tem várias vantagens:
• A conexão mecânica entre o dispositivo de variação de geometria e o atuador permite ter uma posição definida mecanicamente, ao contrário do que acontece com os atuadores VGT do tipo pneumático, em que a posição do dispositivo de variação de geometria depende do equilíbrio que é criado entre as pressões.
• Em atuadores do tipo pneumático, para ter feedback sobre a posição do atuador, é necessário instalar um sensor de posição, enquanto no atuador E-VGT isso não é necessário, porque possui o sensor integrado.
• Cada vez que o motor é ligado, o atuador faz um curso até atingir o batente mecânico



(A); aqui o sistema de controle de posição é zerado e todas as posições subsequentes a serem tomadas pelo atuador são referentes a este ponto.
• Em caso de falha do atuador, há uma mola que mantém as palhetas móveis em uma posição intermediária fixa e permite o funcionamento do motor com desempenho limitado.
EXEMPLO DE APLICAÇÃO EM MOTORES DIESEL PESADOS
Em alguns modelos de motores diesel pesados o comando da turbina e o sinal do sensor de posição integrado são enviados e recebidos via rede CAN entre o atuador e a central de controle do motor.
SENSOR DE ROTAÇÕES DA TURBINA VGT
Algumas aplicações diesel (principalmente pesados) po -
dem utilizar um sensor de rotações da turbina para a central de injeção monitorar a rotação da mesma, o que pode ajudar na proteção e controle do sistema.
É um sensor do tipo indutivo com a finalidade de controlar a rotação máxima da turbina.
Se a rotação ultrapassar o limite máximo, a central de controle do motor detecta falha e em caso de falhas a central limita a atuação do motor elétrico limitando a pressão da turbina, protegendo esta contra excessos de giro e também o próprio motor.
Muito importante conhecer esse sistema para um correto diagnóstico e solução dos problemas relacionados ao sistema de alimentação de ar.
Um bom scanner e o auxílio de um esquema elétrico são fundamentais para análise de parâmetros e diagnóstico preciso desses sistemas.
6 7 8 9 10 11 Março 2024 • oficinabrasil.com.br REPARADOR DIESEL 29
Explorando a potência e precisão, desvendando os segredos da válvula blow-off
Liberando a pressão acumulada e desencadeando o som característico dos motores de alta performance, a Válvula BlowOff emerge como uma peça fundamental, desempenhando um papel crucial na busca por potência e eficiência


Nobres leitores, hoje vamos falar sobre a válvula by-pass ou válvula de recirculação, também conhecida como válvula blow-off.
No circuito de pressurização ela pode estar localizada no tubo de conexão entre a saída da carcaça compressora e o coletor de admissão, em alguns casos está localizada conjugada ao intercooler. Atualmente muitos turbocompressores já utilizam a válvula by-pass integrada na própria carcaça compressora.
Assim como a turbina possui uma válvula de controle chamada wastegate, o compressor também possui seu meio de alívio e controle, a válvula blow-off, utilizada nos veículos de motor ciclo Otto.
Na figura 01 observa-se o diagrama de pressurização desde a entrada do ar em condição de pressão atmosférica no filtro de ar em direção ao rotor compressor (seta cor azul claro) até a saída dos gases de escapamento (seta cor laranja)
Na saída do rotor compressor em azul escuro o ar já se encontra sob alta pressão, temperatura e velocidade dentro dos valores esperado, e está se deslocando para o motor passando pela válvula by-pass (fechada indicado em vermelho no diagrama), intercooler e válvula borboleta (aberta), seguindo para o coletor de admissão, câmara de combustão e escape.


Nessa condição o sistema de gerenciamento do motor tem a informação de pressão e massa de ar em tempo real.
Ao fechar a válvula borboleta se faz necessária a abertura da válvula by pass a fim de manter a pressão e a massa de ar no sistema, sustentando um dos pilares da vedação do turbocompressor e evitar contrapressão no rotor do compressor.
A válvula by-pass pode ser acionada de forma pneumática por uma ligação direta do coletor de admissão após a válvula borboleta ou acionada por comando elétrico através do gerenciamento do eletrônico do motor. (Fig. 02) sistema pneumático, (Fig.03) sistema elétrico.
A deficiência ou falha de operação da válvula by-pass compro-

mete a vida útil do turbocompressor devido à sobrecarga no eixo onde o rotor compressor é alojado. Essa condição desfavorável da contrapressão faz com que o compressor se encontre totalmente fora do mapa de eficiência, caindo a vazão e aumentando a pressão


Nas figuras 04 e 05 é possível observar a atuação da válvula by-pass em conexão ao intercooler,


sistema de comando pneumático. Buscando melhor eficiência na recirculação e respostas mais rápidas do motor alguns turbocompressores possuem uma estrutura prevista na carcaça compressora na qual a válvula by-pass é instalada o mais próximo possível do rotor compressor. Na figura 06 é fácil observar o canal de transferência do ar sob pressão entre o alojamento da válvula by-pass e o rotor do compressor conforme as setas apontam.
Na figura 7 a válvula by-pass por acionamento elétrico também é instalada diretamente na carcaça compressora conforme a seta aponta.

Existe situações de modificações (tunning) nas quais é alterada a trajetória do ar pressurizado no sistema através da instalação de uma válvula by-pass paralela, ou seja, não original em referência ao sistema de pressurização previsto em projeto pelo fabricante do motor (Fig.08). Ao sair, a pressão do sistema provoca um som tipo “espirro” criado pelo ar escapando de um sistema fechado (alívio de pressão) até muitas vezes o pessoal leigo chama esse processo de válvula “espirro”.
Nessa condição quando é solicitada a abertura da válvula by-pass o ar sob pressão é desviado para a atmosfera, ou seja, para fora do circuito provocando um disparo abrupto na rotação do compressor por trabalhar sem carga devido à queda da pressão no circuito, levando ao desequilíbrio harmônico das pressões internas entre carcaça compressora e carcaça de turbina, levando à flambagem da ponta do eixo no lado do compressor, levando ao toque físico dos componentes internos da carcaça central, quebrando o filme de óleo dos mancais radiais entre eixo e carcaça, bem como atrito do compressor com a carcaça compressora, levando à quebra do eixo (Fig.9).
Forte abraço e sucesso a todos!!




 Marcio Cattani
Instagram: @marciocattani marcio.cattani@masterpower.com.br
Marcio Cattani
Instagram: @marciocattani marcio.cattani@masterpower.com.br
e
C.
Fotos
ilustrações: Marcio
TURBOS 30 Março 2024 • oficinabrasil.com.br 1 2 3 4 5 6 7 8 9


















· Vagas limitadas
· Inscrição gratuita
1º

· Informações Direto da Montara exclusivo para reparadores independentes
PRESENCIAL EM ALGUMAS CIDADES! CONSULTE NO MOMENTO DA INSCRIÇÃO
TREINAMENTO DE
Garanta seus Certificados Exclusivos Volkswagen


ASSISTINDO AOS 4° TREINAMENTOS VOCÊ RECEBE O CERTIFICADO PREMIUM VOLKSWAGEN

TREINAMENTOS MINISTRADOS PELO PROFESSOR SCOPINO

HORÁRIO DE BRASÍLIA
19h30
Faça sua inscrição através do site notificiasdaoficinavw.com.br/webinar
leitorvw@noticiasdaoficina.com.br
(11) 3071-4633 (horário comercial)
Veículos autônomos já são utilizados como Transporte de cargas e pessoas - Parte 1
Caminhões, trens e metrôs estão circulando sem a necessidade de um condutor humano para controlar e monitorar funções como a velocidade, frenagens em curvas, paradas e acelerações em subidas


Entrar em um veículo sem uma pessoa no controle pode parecer estranho e gerar receio e isso é natural porque sempre utilizamos transporte conduzido por um profissional treinado, capacitado e habilitado para esta função.
Apenas para exemplificar, podemos perguntar se você entraria em um veículo de transporte mesmo sabendo que não tem uma pessoa na cabine de controle e a resposta imediata seria: acho que não, posso até ir, mas vou com desconfiança.
Para o conhecimento e para tranquilizar a todos, saibam que, mais de 600.000 mil pessoas fazem isso todos os dias, quando utilizam o metrô Linha 4 Amarela na cidade de São Paulo.
Esta é uma das linhas privatizadas e administradas pelo Grupo CCR, que, desde o início de sua operação, nunca teve paralização por grevistas e tem as suas operações diárias mais constantes no transporte público. (Fig.1 e 2)
Para entender melhor como a automação está presente no transporte robotizado, foram criados níveis de classificação para veículos (carros/caminhões) e trens.




avançados de assistência ao motorista ou ADAS. O veículo pode controlar a direção e a aceleração/desaceleração. Aqui, a automação fica aquém da direção autônoma porque um ser humano se senta no banco do motorista e pode assumir o controle do carro a qualquer momento.
permanecer alerta e pronto para assumir o controle caso o sistema não consiga executar a tarefa.
Nível 4 (Alta Automação de Condução)
Classificação de automação de 0 a 5 para veículos
Nível 0 (sem automação de direção)
A maioria dos veículos nas estradas hoje são de Nível 0, controlados manualmente. O ser humano fornece o controle de direção dinâmica.
Nível 1 (Assistência ao Condutor)
Este é o nível mais baixo de automação. O veículo con-
Só para ilustrar, o robô mais pesado e longo do planeta está na Austrália, é um trem de mineração com 2 Km de extensão. (Fig.3 e 4)
ta com um único sistema automatizado de assistência ao motorista, como direção ou aceleração (cruise control). O controle de cruzeiro adaptativo, em que o veículo pode ser mantido a uma distância segura atrás do próximo carro, qualifica-se como Nível 1 porque o motorista humano monitora os outros aspectos da condução, como direção e frenagem.
Nível 2 (automação de direção parcial)
Isso significa sistemas
Nível 3 (automação de direção condicional)
O salto do Nível 2 para o Nível 3 é substancial do ponto de vista tecnológico, mas sutil, se não negligenciável, do ponto de vista humano.
Os veículos de nível 3 possuem capacidades de detecção ambiental e podem tomar decisões informadas por si próprios, como acelerar para ultrapassar um veículo lento. Mas, eles ainda exigem controle humano. O motorista deve
A principal diferença entre a automação de Nível 3 e Nível 4 é que os veículos de Nível 4 podem intervir se algo der errado ou se houver uma falha no sistema. Neste sentido, estes carros não requerem interação humana na maioria das circunstâncias. No entanto, um ser humano ainda tem a opção de substituir manualmente.
Os veículos de nível 4 podem operar no modo autônomo. Mas até que a legislação e a infraestrutura evoluam, só poderão fazê-lo dentro de uma área limitada, geralmente um ambiente urbano onde as velocidades máximas atingem
Antonio Gaspar de Oliveira agaspar@hotmail.com
Fotos e ilustrações: Gaspar
TECNOLOGIA 34 Março 2024 • oficinabrasil.com.br 1 2 3 4


uma média de 50km/h. Isso é conhecido como cerca geográfica. Como tal, a maioria dos veículos de nível 4 existentes são voltados para o compartilhamento de viagens.
Classificação de automação para trens
A indústria possui uma escala chamada Grades of Automation (GoA) para trens, que vai de GoA0 a GoA4.
GoA0: Sem automação, toda a condução é feita por um humano.
GoA1: Um humano dá partida e para o trem, mas ele pode viajar automaticamente pelo percurso, com a capacidade do maquinista de intervir em caso de emergência.
GoA2: O trem vai de uma
parada a outra automaticamente, mas o maquinista permanece no local para anular o sistema, se necessário, e para realizar procedimentos como verificar se a plataforma está livre de passageiros antes de iniciar a sequência de partida.
GoA3: O trem pode viajar sozinho, e o faz, mas sempre haverá uma pessoa a bordo, que poderá assumir os controles, se necessário. No entanto, eles podem não estar na cabine, podem estar verificando passagens, fazendo anúncios, abrindo e fechando portas etc.
GoA4: Automação total, sem necessidade de pessoal ou condutor no trem em nenhum momento. Toda a segurança e condução dos passageiros são

realizadas automaticamente.
As composições do metrô da Linha 4 Amarela na cidade de São Paulo estão classificadas no Nível GoA4, permitindo que as composições sejam operadas de modo automático, como robôs.
O Centro de Controle Operacional do metrô Linha 4 Amarela, através de um sistema chamado ATC (Automatic Train Control), controla a locomoção de todos os trens. Caso se aproxime de outro que esteja parado, o sistema identifica a necessidade de reduzir a velocidade e se for preciso também realiza a parada total da composição. (Fig.5)
O embarque no metrô linha 4 Amarela só permitido quando a composição está estacionada na plataforma, que possui portas de vidro que impedem a aproximação da linha, evitando que alguém caia e interrompa o tráfego. Assim que as portas de vidro se abrem, as portas do metrô também se abrem e os passageiros podem desembarcar e em seguida os demais entram na composição para seguir viagem. Até os controles de abertura e fechamento das portas são realizados de forma automatizada. (Fig.6)
Utilizando-se das redun-

dâncias e pensando pela segurança, no primeiro e no último vagão da composição existem ainda as cabines de controle, porém sem o condutor, mas caso seja necessário, um condutor pode acessar a cabine, remover uma cobertura no painel e todos os controles estarão à disposição para movimentar a composição de forma manual. (Fig.7)
Uma grande vantagem dos trens sobre os caminhões está no ambiente confinado dos túneis e trilhos, além das viagens constantes e repetitivas.
O ambiente de um caminhão autônomo é muito diferente e com infinitas variáveis durante o trajeto, que podem interferir e até impedir que a viagem seja concluída.
Na estrada, o caminhão
não estará sozinho e o espaço da rodovia será compartilhado com outros tipos de veículos, sendo a maioria de Nível 0, além das motos, bicicletas e a possível presença de pessoas e até animais na pista.
Boa parte dos caminhões novos estão equipados com sistemas que permitem a classificação de Nível 2, no qual sistemas avançados de assistência ao motorista, ou ADAS, cumprem funções importantes na segurança do trânsito nas estradas. (Fig.8)
Continua na próxima edição

Março 2024 • oficinabrasil.com.br TECNOLOGIA 35
Antonio Gaspar de Oliveira é Tecnólogo
5 6 7 8
TODOS OS CONTEÚDOS ESCRITOS POR COLABORADORES PUBLICADOS EM NOSSO JORNAL SÃO DE INTEIRA E TOTAL RESPONSABILIDADE DOS AUTORES QUE OS ASSINAM.
Tecnologia automotiva: os avanços significativos na indústria automotiva
Motores a combustão, híbridos e elétricos, Inteligência Artificial e Aprendizado de Máquina, tudo isso tem transformado a indústria automotiva, tornando os veículos mais seguros, eficientes, sustentáveis e conectados

Oavanço da tecnologia nos motores automotivos tem sido uma constante ao longo das últimas décadas, impulsionado por uma série de fatores, incluindo a busca por maior eficiência energética, redução de emissões, melhor desempenho e integração de sistemas inteligentes. Algumas das principais tendências e avanços na tecnologia de motores automotivos incluem:
ELETRIFICAÇÃO
A transição para veículos elétricos (VEs) ou híbridos tem sido uma das maiores mudanças na indústria automotiva. Motores elétricos estão se tornando mais comuns, proporcionando uma alternativa mais eficiente em termos de energia e reduzindo a dependência de combustíveis fósseis. Fig1
GESTÃO ELETRÔNICA DO MOTOR (ECU)
O controle computadorizado dos motores permitiu otimizar o desempenho, melhorar a eficiência de combustível e reduzir as emissões. Sensores avançados e algoritmos complexos ajustam continuamente a operação do motor em tempo real. Fig2
MATERIAIS LEVES


A utilização de materiais mais leves, como ligas de alumínio e compósitos, contribui para a redução de peso dos veículos, o que, por sua vez, melhora a eficiência do combustível.
TURBOCOMPRESSORES E SOBREALIMENTADORES
A implementação de turbocompressores e sobrealimentadores aumentou a eficiência dos motores a combustão interna, permitindo que gerem mais potência com menor consumo de combustível. Fig3
TECNOLOGIA DE INJEÇÃO DIRETA
A injeção direta é uma tecnologia utilizada em motores de combustão interna, em que o combustível é injetado diretamente nos cilindros do motor, em vez de passar pelo coletor de admissão. Essa abordagem proporciona diversos benefícios em termos de eficiência, desempenho e controle de emissões. Aqui estão alguns aspectos importantes relacionados à injeção direta:
Precisão na Injeção: Na injeção direta, o combustível é injetado diretamente na câmara de combustão, permitindo um controle mais preciso sobre a quantidade de combustível entregue. Isso possibilita uma melhor mistura ar-combustível e, consequentemente, uma combustão mais eficiente.
Eficiência de Combus -

tão: Ao entregar o combustível diretamente na câmara de combustão, a injeção direta contribui para uma melhor vaporização do combustível, resultando em uma queima mais completa. Isso melhora a eficiência térmica do motor, aumentando a potência e reduzindo o consumo de combustível.
Redução de Emissões: A injeção direta ajuda a reduzir as emissões de poluentes, pois permite um controle mais preciso da queima do combustível. Isso é especialmente importante para atender a regulamentações ambientais mais rigorosas.
Desempenho Melhorado: A capacidade de controlar a injeção de combustível de forma mais precisa também beneficia o desempenho do motor. Isso pode resultar em uma resposta mais rápida do acelerador, maior torque em diferentes faixas de rotação e melhor eficiência em altas cargas.
Sistemas de Combustível de Alta Pressão: A injeção di-
reta muitas vezes requer sistemas de combustível de alta pressão para garantir uma entrega precisa do combustível. Isso é alcançado por meio de bombas de alta pressão e injetores capazes de suportar pressões significativamente maiores do que aquelas usadas em sistemas de injeção indireta.
Resfriamento da Câmara de Combustão: A injeção direta pode permitir estratégias de resfriamento mais eficazes, já que o combustível pode ser injetado durante a compressão, ajudando a reduzir a temperatura da câmara de combustão e a prevenir a detonação.
Variações na Configuração: Existem diferentes tipos de injeção direta, como a injeção direta estratificada, na qual o combustível é injetado de maneira a criar camadas distintas na câmara de combustão para otimizar a eficiência em diferentes condições de operação.
Apesar dos benefícios, a injeção direta também enfrenta desafios, como o acúmulo de depósitos carboníferos nos
Jordan Jovino
CONSULTOR OB 36 Março 2024 • oficinabrasil.com.br
Ilustrações: Jordan Jovino
1 2 3
O verdadeiro manual de instruções para o reparador!
O FÓRUM
OFICINA
BRASIL A VERDADEIRA FONTE DE CONHECIMENTO DO REPARADOR!
Conte com os especialistas mais qualificados em reparação para resolver os desafios mais complexos que surgem na oficina mecânica!









Confira quem acaba de entrar no Fórum para ajudá-lo a solucionar os casos mais complexos!
injetores, que pode impactar o desempenho ao longo do tempo. No entanto, as melhorias contínuas na tecnologia e nos materiais têm contribuído para minimizar esses problemas.
SISTEMAS HÍBRIDOS
Os sistemas híbridos em motores automotivos combinam dois ou mais tipos diferentes de fontes de energia para propulsão, geralmente um motor de combustão interna (MCI) e um motor elétrico. Esses sistemas têm ganhado popularidade devido à sua capacidade de oferecer eficiência energética aprimorada e redução de emissões. Existem basicamente três tipos principais de sistemas híbridos:
Híbridos em Série:
Nesse tipo de sistema, o motor de combustão interna (MCI) não está diretamente conectado às rodas. Em vez disso, o MCI gera eletricidade, que é então usada para alimentar um motor elétrico ou recarregar a bateria.
O motor elétrico é responsável pela propulsão direta do veículo. Exemplos incluem o Chevrolet Volt.
Híbridos em Paralelo:
Tanto o motor de combustão interna quanto o motor elétrico estão conectados diretamente às rodas.
O veículo pode ser impulsionado pelo MCI, pelo motor elétrico ou por ambos, dependendo das condições de condução e do modo de operação escolhido.
Exemplos incluem o Toyota Prius.
Híbridos Plug-in (PHEV):
Esses veículos híbridos possuem uma bateria maior que pode ser recarregada através de uma fonte externa, como uma tomada.


Eles podem operar no modo totalmente elétrico por distâncias limitadas antes de recorrer ao motor de combustão interna ou operar em conjunto com ele.
Exemplos incluem o Chevrolet Volt e o Mitsubishi
Outlander PHEV.
Alguns componentes comuns em sistemas híbridos incluem:
Motor de Combustão Interna (MCI): geralmente, um motor a gasolina, diesel ou mesmo a gás.
Baterias de íon de lítio são comuns devido à sua densidade de energia.
Sistema de Controle Eletrônico: gerencia a distribuição de energia entre o MCI e o motor elétrico, otimizando a eficiência e o desempenho.
Sistema de Recuperação de Energia (Regenerativo): converte a energia cinética gerada durante a desaceleração e frenagem em eletricidade para recarregar a bateria.
Os benefícios dos sistemas híbridos incluem a redução do consumo de combustível, menor emissão de poluentes e, em alguns casos, a capacidade de operar em modo totalmente elétrico em distâncias curtas. Esses sistemas são parte integrante dos esforços da indústria automotiva para atender a padrões de eficiência e emissões mais rigorosos. Fig5
INTELIGÊNCIA ARTIFICIAL E MACHINE LEARNING
A aplicação de Inteligência Artificial (IA) e Machine Learning (ML) na indústria automotiva está transformando significativamente a maneira como os veículos são projetados, fabricados e operados. Aqui estão algumas áreas-chave em que essas tecnologias estão desempenhando um papel crucial:
Motor Elétrico: um motor que usa eletricidade armazenada em uma bateria para gerar energia cinética e impulsionar o veículo.
Bateria de Alta Voltagem: armazena a energia elétrica para uso pelo motor elétrico.
Assistência ao Motorista e Condução Autônoma: Sistemas de assistência ao motorista, como controle de cruzeiro adaptativo, assistência de estacionamento e sistemas de alerta de colisão utilizam IA para processar dados de sensores e câmeras.
A condução autônoma depende fortemente de algoritmos de ML para a tomada de decisões em tempo real, avaliação de cenários e navegação segura.
“Consultor OB” é uma editoria em que as matérias são realizadas na oficina independente, sendo que os procedimentos técnicos efetuados na manutenção são de responsabilidade do profissional fonte da matéria. Nossa intenção com esta editoria é reproduzir o dia a dia destes “guerreiros” profissionais e as dificuldades que enfrentam por conta da pouca informação técnica disponível. Caso queira participar desta matéria, entre em contato conosco: redacao@oficinabrasil.com.br Março 2024 • oficinabrasil.com.br
38
CONSULTOR OB
Fig4
4 5
Manutenção Preditiva:
Utilização de algoritmos de ML para analisar dados provenientes de sensores veiculares, identificando padrões e antecipando falhas mecânicas antes que elas ocorram.
Ajuda na prevenção de quebras inesperadas e reduz os custos de manutenção.
Navegação Inteligente:
Sistemas de navegação alimentados por IA podem oferecer rotas mais eficientes com base nas condições de tráfego em tempo real, otimizando o tempo de viagem e economizando combustível.
Reconhecimento de Voz e Controle por Gestos:
Sistemas de IA permitem o reconhecimento de voz e gestos, melhorando a interface homem-máquina e permitindo que os motoristas controlem funções do veículo sem tirar as mãos do volante.
Otimização de Desempenho do Motor:
Algoritmos de ML são utilizados para ajustar dinamicamente os parâmetros do motor com base nas condições de condução, maximizando a eficiência de combustível e o desempenho.
Personalização da Experiência do Usuário:
- Sistemas de IA aprendem as preferências do motorista, ajustando automaticamente configurações como posição do assento, temperatura e configurações de entretenimento.
Segurança Veicular:
IA é usada para analisar padrões de comportamento do motorista e do tráfego, identificando potenciais situações de risco e fornecendo alertas antecipados.
Redes Neurais para Visão Computacional:
Redes neurais profundas são empregadas para processar informações visuais de câmeras e sensores, possibilitando o reconhecimento de objetos,
pedestres, sinalizações e outras características do ambiente ao redor do veículo.
Comunicação Veículo-Veículo (V2V) e Comunicação Veículo-Infraestrutura (V2I):
IA facilita a comunicação entre veículos e infraestrutura, permitindo a troca de informações sobre condições de tráfego, acidentes, obras e outros eventos relevantes para a segurança e eficiência do tráfego.
Desenvolvimento de Veí-
criar componentes mais leves e complexos, contribuindo para a eficiência geral dos motores. Conectividade e Comunicação
A conectividade e a comunicação na indústria automotiva referem-se à capacidade dos veículos de se comunicarem entre si, com infraestruturas de tráfego, dispositivos externos e centros de dados. Essa evolução tecnológica está desempenhando um papel
móveis, serviços de streaming e conectividade com a internet para fornecer entretenimento a bordo, informações em tempo real e acesso a aplicativos.
Navegação Conectada:
Sistemas de navegação utilizam informações em tempo real sobre condições de tráfego, construções e eventos para fornecer rotas mais eficientes e atualizações dinâmicas.
Comunicação Veículo-Veículo (V2V):
garantindo que os sistemas estejam sempre atualizados.
Segurança Cibernética: A comunicação constante entre veículos e sistemas externos destaca a importância da segurança cibernética. Mecanismos de proteção são implementados para evitar ataques e garantir a integridade dos sistemas veiculares.
Pagamento Integrado e Serviços de Mobilidade: Sistemas que permitem pagamentos automáticos em pedágios, estacionamentos e outros serviços relacionados à mobilidade.

culos Autônomos em Simulações Virtuais:
Algoritmos de ML são usados para treinar e simular o comportamento de veículos autônomos em ambientes virtuais, permitindo aperfeiçoamento antes da implementação no mundo real.
O uso crescente de IA e ML na indústria automotiva não apenas melhora a segurança e eficiência, mas também impulsiona inovações contínuas, moldando o futuro da mobilidade. Fig6
Manufatura Avançada
Tecnologias de manufatura avançadas, como a impressão 3D, estão sendo utilizadas para
fundamental na melhoria da experiência do usuário, na segurança veicular e na eficiência operacional. Aqui estão alguns aspectos importantes da conectividade e comunicação automotiva:
Telemática e Serviços Remotos:
Sistemas de telemática permitem que os veículos se comuniquem com centros de dados, possibilitando serviços como monitoramento remoto, localização veicular, diagnóstico remoto e atualizações de software.
Sistemas de Entretenimento Conectados:
Integração de dispositivos
Permite que os veículos comuniquem informações uns com os outros, como localização, velocidade e intenções, para melhorar a segurança e a prevenção de acidentes.
Comunicação Veículo-Infraestrutura (V2I):
Integração de veículos com infraestruturas de tráfego, semáforos e sistemas de controle de tráfego para otimizar o fluxo de tráfego e melhorar a segurança.
Atualizações Over-the-Air (OTA):
Permite a atualização remota de software e firmware nos veículos, eliminando a necessidade de visitas à oficina e
Inteligência Artificial e Assistentes Virtuais:
Utilização de IA para aprimorar a interação homem-máquina, possibilitando assistentes de voz e comandos de controle mais intuitivos.
Redes 5G:
A implantação de redes 5G permite uma comunicação mais rápida e confiável entre veículos e infraestrutura, facilitando aplicações avançadas, como comunicação V2V em tempo real.
Dados e Análise Preditiva:
Coleta e análise de dados em tempo real para oferecer informações sobre o desempenho do veículo, condições de tráfego e previsões meteorológicas, entre outros.
A conectividade e a comunicação automotiva estão moldando a próxima geração de veículos, tornando-os mais inteligentes, seguros e convenientes. Essas tecnologias também são fundamentais para o desenvolvimento de futuros serviços de mobilidade e veículos autônomos.
6 Março 2024 • oficinabrasil.com.br
OB 39
CONSULTOR
Como Diferenciar Problemas Mecânicos de Eletroeletrônicos - Parte I
Veja em detalhes o uso de diferentes equipamentos e testes específicos, proporcionando uma sequência lógica de diagnóstico. Com exemplos práticos, evitaremos desmontagens desnecessárias
Laerte Rabelo

Demonstraremos minuciosamente a aplicação de diversos equipamentos e testes específicos, destinados a localizar com precisão o componente ou sistema responsável pela falha. Por meio de exemplos práticos, delinearemos uma sequência lógica de testes, contribuindo para evitar desmontagens desnecessárias e, consequentemente, agilizar o processo de diagnóstico (Fig. 1)
1. Que caminho a seguir?
Antes de iniciar o diagnóstico é fundamental falar com o cliente acerca do problema do veículo, já que ele em muitas ocasiões tem a resposta do problema em sua boca.
Primeiramente, desenvolva um plano de ação no qual colocará todos os componentes que fazem parte do sistema suspeito, assim você fará os testes necessários para cada problema ou falha crítica, nunca esquecer ou negligenciar os testes básicos como pressão de combustível ou compressão do motor, que são tão importantes como as análises avançadas. Não se esqueça de ter em mãos as especificações reais oriundas de fontes confiáveis, jamais use valores generalizados. Vale lembrar ao amigo reparador que problemas mecânicos afetam e muito o funcionamento dos sistemas eletrônicos, podendo confundir o técnico na determinação da causa da falha.
2. Análise de problemas de origem mecânica


A maioria dos motores de combustão interna funciona com base em um ciclo de 4 tempos, cujo princípio é o ciclo termodinâmico Otto (motores movi-
dos a gasolina, etanol ou GNV) e o ciclo termodinâmico Diesel (motores movidos a óleo Diesel). Portanto, sua eficiência é baseada na variação de temperatura


tanto no processo de compressão adiabática (não há troca de calor com o meio externo), quanto no processo de admissão da massa ar + combustível (ciclo Otto) ou somente ar (ciclo Diesel) com pressão constante.
Em outras palavras, para o motor de combustão interna trabalhar com eficiência ele deve estar com seus componentes móveis e fixos (válvulas, junta do cabeçote, anéis de segmento, cabeçote, dentre outros) em perfeito funcionamento. Veja os 4 tempos do ciclo Otto. (Fig.2)
2.1 Teste de compressão relativa
É um teste muito fácil de realizar, além de ser rápido e conclusivo. Consiste, basicamente, na análise da queda de tensão da bateria no momento da partida, causada pelo consumo de
corrente do motor de partida ao movimentar o motor do veículo. Este consumo depende dentre outras coisas da qualidade da vedação de cada cilindro, ou seja, quanto melhor a vedação, ou estado dos componentes mecânicos do motor, maior será a pressão de compressão e, consequentemente, maior o consumo de corrente utilizada pelo motor de partida, que se refletirá numa maior queda de tensão medida nos bornes da bateria.
Para realizá-lo o técnico automotivo deve estar de posse de um osciloscópio que faça a leitura de tensão alternada (acoplamento AC). Para capturar o sinal basta inserir as pontas de prova nos bornes positivo e negativo da bateria. (Fig.3)
Deve-se desconectar algum componente eletrônico vital para o funcionamento do motor (sensor de rotação, bicos injetores, rotação e fase, dentre outros) para o mesmo não entrar em funcionamento e, finalmente,
Março 2024 • oficinabrasil.com.br CONSULTOR OB 40 1 2 3 4



escolher os valores adequados de tensão e tempo na tela do osciloscópio, para enquadramento vertical e horizontal do sinal respectivamente. (Fig.4)
O momento da captura do sinal utilizando o equipamento Raven Scanner 3 em um Corsa Hatch ano 2003, em perfeito estado. (Fig.5)
Analisando, detalhadamente, o sinal capturado, observamos a uniformidade da queda de tensão da bateria, atestando que os cilindros estão com pressões de compressão equivalentes. (Fig.6)
Alguns equipamentos já trazem em seu software a construção de um gráfico em forma de barras no final do teste de compressão relativa, com o obje-






her os valores de tensão e tempo para enquadramento vertical e horizontal do sinal na tela do osciloscópio e dar partida no motor, observe o formato e características deste sinal.
(Fig.12)
tivo de facilitar a visualização do resultado final do teste. (Fig.7)
Bom, mas alguns poderão perguntar: como será o sinal para um motor com problema mecânico? Para responder a esta possível indagação lanço mão de imagens, que como se afirma, dizem mais que mil palavras.
Identificamos que há um intervalo no sinal sem queda de tensão da bateria, o que identifica perda de compressão em um ou mais cilindros do motor. Neste caso em especial existia uma falha nos cilindros 1 e 2. (Fig.8)
Após a correção, substituição da junta do cabeçote, temos o sinal com o motor em funcionamento normal. (Fig.9)
Um caso em que o veículo chegou ao técnico Paulo Rogério, após passar por várias oficinas, onde foram substituídos vários componentes como bomba de baixa e alta pressão de combustível e bicos injetores, sem, contudo, obterem sucesso
na identificação da falha. (Fig.10) Paulo, sem desmontar uma arruela, realizou o teste de compressão relativa e identificou um cilindro com pressão de compressão inferior aos demais, o técnico levou apenas 5 segundos para realizar o teste e concluir o diagnóstico.
Cabe salientar que o valor de compressão individual de cada cilindro deve ser verificado com um medidor de compressão, pois o teste de compressão relativa apenas compara as pressões dos cilindros. Por exemplo, falta de vedação devido a junta de cabeçote danificada ou problemas nas válvulas serão identificadas por este teste, todavia, baixa pressão de compressão em todos os cilindros já não será vista a partir desta análise.
2.2 Teste com transdutor de pressão na partida
No início da matéria apresentei os quatro tempos do motor e, dentre estes, o tempo de admissão, que tem a função de admitir a mistura ar/combustível para os motores ciclo Otto e apenas ar para os motores ciclo Die-
sel. É neste tempo que a pressão dentro do motor fica abaixo da pressão atmosférica, em motores aspirados, devido à descida do pistão que sai do ponto morto superior (PMS) para o ponto morto inferior (PMI). A análise do vácuo gerado devido a esse movimento é tão importante quanto a pressão de compressão.
Desta forma, utilizando um transdutor de pressão, que consiste, basicamente, de uma pastilha piezoelétrica que transforma variações de pressão em sinais elétricos instalado no coletor de admissão, podemos, facilmente, verificar o vácuo que cada cilindro está gerando no momento da admissão. Este teste pode ser realizado em dois regimes de funcionamento do motor: na partida ou em marcha lenta. Para esta matéria vamos iniciar mostrando o teste na partida.
Para realizar este teste, o reparador deve inserir o transdutor de pressão no coletor de admissão. (Fig.11)
Desligar algum componente eletroeletrônico vital, para não permitir seu funcionamento (sensor de rotação, fase, bicos injetores, dentre outros). Escol-
Observe, amigo reparador, que o vácuo gerado individualmente por cada cilindro, demonstrado por cada ponto inferior (indicado pelas setas), mostra que todos os cilindros estão com o valor de vácuo semelhantes, indicando que os componentes mecânicos estão em bom estado de funcionamento.
Observe em destaque os pontos que indicam o vácuo gerado pelos cilindros, mostrando sua regularidade, atestando o bom funcionamento do motor.
(Fig.13)
Amigos reparadores, com esses exemplos procurei apresentá-los a essa fantástica ferramenta que em mãos capacitadas realiza verdadeiros prodígios ao mostrar por meio de sinais elétricos as variações de pressão que ocorrem no interior do motor, realizando quase um exame de “raio-x” decifrando as falhas quase invisíveis aos olhos menos atentos. Para ter acesso a mais casos de aplicação desta ferramenta visite o fórum do Jornal Oficina Brasil, o maior fórum do setor de reparação do Brasil.
Continua na próxima edição... Até a próxima!
Março 2024 • oficinabrasil.com.br CONSULTOR OB 41
oficina L.Rabelo 5 6 7 8 9 10 11 12 13
Professor José Laerte Rabelo Nobre Filho é técnico em manutenção automotiva, consultor técnico do SIMPLO Manuais Técnicos Automotivos e sócio-proprietário
da
Confira as ofertas de peças e equipamentos!

42 Março 2024 oficinabrasil.com.br



43 Março 2024 oficinabrasil.com.br







44 Março 2024 oficinabrasil.com.br TEM NOVIDADES NA MOTORS IMPORTS! TEM NOVIDADES NA MOTORS IMPORTS! www. motorsimports .com.br Entre em contato com uma de nossas lojas e conheça todas as nossas linhas de motores, suspensão, freios e câmbio. Ganhadores do Prêmio Maiores e Melhores 2023 Itajaí/SC 47 3404-5863 São José/SC 48 3249-4000 Curitiba/PR 41 3028-3333
Alegre/RS 51 3368-3300
Paulo/SP 11 3738-3738
19 3772-3150
de Janeiro/RJ 21 3037-1237 Brasília/DF 61 3048-6600 motorsimportsbr Lançamento 36866 - ARTICUL. AXIAL FORD RANGER 17... Lançamento 37928 - RADIADOR ÓLEO SPRINTER 2.2/3.2 12... Lançamento 37983 - DISCO FREIO DIANT. TESLA MODEL 3 (5YJ3) 18... Lançamento 37258 - FILTRO COMBUST. BMW X5 3.0 19/20 Lançamento 36706 - BRONZINA MANCAL MERCEDES A200/B200 13... STD As melhores ofertas de peças e equipamentos PARA ANUNCIAR, ENTRE EM CONTATO: (11) 9 98351-8871 julianna.miras@oficinabrasil.com.br
Porto
São
Campinas/SP
Rio

45 Março 2024 oficinabrasil.com.br
EMPRESA PARCEIRA GOE, WEGA LANÇA LINHA EXCLUSIVA DE FERRAMENTAS PARA APLICADOR E INOVA PORTFÓLIO
A Wega, uma das maiores fabricantes de filtros automotivos para o mercado de reposição, não para de inovar e está lançando uma linha de ferramentas próprias para o profissional da oficina: ferramenta para sacar copo acrílico do filtro com separador, um calibrador de folga de velas e um alicate para conectores do filtro de combustível.
A FERRAMENTA PARA SACAR COPO ACRÍLICO auxilia a aderência na retirada do copo acrílico dos filtros de combustível com separador de água.
O CALIBRADOR DE FOLGA DE VELAS é uma ferramenta utilizada para medir a distância entre os eletrodos de uma vela de ignição.
O ALICATE PARA CONECTORES DO FILTRO

DE COMBUSTÍVEL
facilita a remoção e instalação de conectores rápidos ou encaixes usados nos sistemas de filtro de combustível de veículos automotivos.
Com essa nova gama de ferramentas, a Wega reforça seu crescimento no mercado, oferecendo não só uma vasta linha de filtros automotivos, mas também ferramentas especializadas que atendem às demandas específicas dos profissionais de oficina e entusiastas automotivos. “Essa novidade reflete o
constante esforço da Wega em proporcionar inovações que elevam os padrões da indústria de reposição automotiva” Explica Thuanney Castro.
Além de fabricar velas de ignição e velas aquecedoras, a Wega, também fornece filtros de ar, óleo, cabine e, combustível, contempla em seu portfólio filtros de motores náuticos, câmbio automático, bateria e ecológico.
Antenada com a agenda ESG, a empresa mantém parceria com a Associação Brasileira de Filtros (ABRAFILTROS) no programa de Reciclagem e Descarte Consciente dos Filtros Usados, participando das ações e decisões do órgão na preocupação com o meio ambiente.
Para mais informações, catálogos, lançamentos, assistência e dicas técnicas, acesse https://wegamotors. com


46 Março 2024 oficinabrasil.com.br
INFORME PUBLICITÁRIO
Uma ferramenta fundamental para todos os mecânicos
Veremos nesta aula uma ferramenta que serve como analisador de falhas e que apresenta testes básicos e fundamentais que fazem com que a precisão no diagnósticos e velocidade de trabalho sejam melhorados
 Professor Scopino scopino@automecanicascopino.com.br
Professor Scopino scopino@automecanicascopino.com.br

Atarefa diária de fazer diagnósticos e correções de falhas é algo que requer muito conhecimento, informações técnicas e ferramentas. Mas quando se fala em equipamentos eletrônicos vem sempre em primeiro lugar na cabeça dos reparadores os scanners, equipamentos de diagnósticos que são conectados até centrais eletrônicas e que apresentam a falha em forma de código ou até mesmo de forma escrita. Mas esse caminho não é o único e muito menos é 100% preciso.
FERRAMENTAS PORTÁTEIS AUXILIAM NA PRODUTIVIDADE DA OFICINA MECÂNICA
Então, ao invés de pensarmos só no scanner, vamos pensar em analisadores que facilitam muito o diagnóstico.
Esse tipo de ferramenta portátil pode e vai fazer testes

e simulações com precisão e velocidade, pois é portátil e intuitivo.
Exemplo de funções:
Executa todo tipo de serviço, incluindo injeção de energia, medição, teste de aterramento, verificações de polaridade, teste de continuidade e ativação de componentes.
Com um toque no interruptor central é possível verificar a
continuidade, bem como acionar componentes elétricos tais quais ventiladores, relés, etc.
Identifica instantaneamente circuitos positivos, negativos e abertos.
Possui lanterna embutida para a utilização em ambientes com pouca iluminação.
12V ou 24V. Alimentação fornecida pela bateria do veículo.
INJETAR ALIMENTAÇÃO ELÉTRICA, POSITIVA OU NEGATIVA, AUXILIA OS TESTES DE ATUADORES E TORNA A OFICINA MAIS PRODUTIVA
Além de testes rápidos, a simulação é algo sensacional, pois de forma bem rápida podemos testar lâmpadas, ventiladores, bomba elétrica de combustível, injetores, resistores, circuitos, sensores de freio ABS, sensores da injeção eletrônica, enfim, teste de sinais de entrada como sensores e testes de comandados, como os atuadores. Aquela dúvida, será que a falha é na peça ou no circuito? Será que é um mau contato? E se eu trocar a peça e mesmo a nova não funcionar? E se eu passar um orçamento e depois descobrir que errei nos testes e no diagnóstico?
São muito as dúvidas na cabeça do reparador automotivo!
COMENTÁRIOS DE REPARADOR PARA REPARADOR
Acredito que em um futuro próximo, cada reparador ou reparadora terá suas próprias ferramentas, ou parte delas. E como exemplo, o analisador de polaridade complementa de uma forma simples e consideravelmente barata vários testes necessários no dia a dia da reparação automotiva, tornando a oficina mais produtiva, pois é mais rápido o serviço inicial, que são os testes e diagnósticos. Afinal trocar peças é, geralmente, um serviço mais simples e rápido, mas saber qual peça trocar na certeza, é um passo muito importante.
É mais tecnologia nos motores e maior a necessidade de conhecimento técnico. Pensem nisto.
Abraços e até a próxima edição com mais dicas sobre tecnologia em motores modernos.

 Professor Scopino, Mecânico de Autos Profissional e Embaixador da marca Pierburg no Brasil
Professor Scopino, Mecânico de Autos Profissional e Embaixador da marca Pierburg no Brasil
Março 2024 • oficinabrasil.com.br TÉCNICA 47
TODOS OS CONTEÚDOS ESCRITOS POR COLABORADORES PUBLICADOS EM NOSSO VEÍCULO SÃO DE INTEIRA E TOTAL RESPONSABILIDADE DOS AUTORES QUE OS ASSINAM.
DO FUSCA AO TESLA 48
Interpretação de esquema elétrico em diversas formas
Esquema elétrico é uma ferramenta indispensável no diagnóstico elétrico, nessa matéria vamos conhecer o esquema original e alternativo
Marcio Ferreira

Conforme tratamos nas outras aulas, o esquema elétrico é para nossa profissão como o alicerce de um grande prédio, e hoje vamos ensinar como interpretar o esquema elétrico, tanto o original como os alternativos.
Vamos tomar como base parte do esquema elétrico do airbag de um New Fiesta.
Começando da parte de cima do lado esquerdo identificamos a central de distribuição elétrica PJB, conseguimos identificar que o que alimenta o sistema é o fusível 4 de 7,5 amperes, o circuito que vai alimentar o sensor de classificação do passageiro é dividido em três partes identificadas pelos códigos CBP04A, CBP04D e CBP04E, temos também uma derivação através do ponto S04 que vai para a página 46-2 que é outra página do mesmo esquema elétrico, mais abaixo temos o conector C33B e daí se conectar ao pino 1 do conector B114 do sensor de classificação do passageiro.
Do lado direito do circuito ele informa a bitola do fio e também a abreviação da cor, no caso VT abreviação de violeta em inglês.
O sensor de peso do passageiro B116 tem conector C116 de três fios.


Da mesma forma podemos ver o código do circuito do lado esquerdo, a bitola do fio, que no caso os três são 0.35 e abreviação em inglês cinza com amarelo, azul com branco e amarelo com violeta.
Na parte de baixo vemos o aterramento do sensor, ele está ligado no pino 14, a bitola é 0.50, a fiação passa por uma derivação S45D, deriva para outro ponto do esquema elétrico na página 46-6 e pas -



Março 2024 • oficinabrasil.com.br


sa pelo conector C33B e vai ao ponto de aterramento G13.
Temos também o sensor de tensão do cinto de segurança
B 115 no conector C115. As três fiações de bitola 0.35 e de cores azul com marrom, verde, e amarelo

com azul, estes quatro últimos o aterramento e os três fios, vão no conector C114.
Também temos os dois fios de rede CAN de alta velocidade que vão para o circuito 14C-2, os dois fios de bitola 0.50 - um da cor branca e o outro branco com azul.
Podemos perceber também no sensor central as informações do que são cada circuito: alimentação, valor de referência, sinal e GND.
Vemos no esquema elétrico original que há várias informações a respeito de

cada fiação, mas mesmo o esquema elétrico original pode ter falhas, às vezes tem uma atualização de projeto em um determinado veículo e não atualizada no esquema elétrico.
Veja também que essa parte que descrevemos é apenas um setor do sistema de airbag, mas a informação é padrão e encontramos esse tipo em todo o esquema elétrico original.
No mercado brasileiro, temos quatro principais empresas que fornecem bons esquemas elétricos para ser utilizados, a seguir vamos analisar a mesma parte do esquema elétrico feita por uma destas empresas.
Temos praticamente a
mesma informação, os dois sensores ligados no sensor de classificação do passageiro, a numeração de cada borne, a cor da fiação, os fios da rede CAN, a fiação de alimentação e o aterramento do sensor, não temos somente a informação dos conectores e derivações que podem ter em um circuito e neste caso a cor dos fios da rede diverge do original, mas pode ter sido verificado em um carro que tinha outra cor de fio.
Nas próximas aulas vamos fazer mais explicações de esquemas elétricos de outros sistemas do veículo.
Março 2024 • oficinabrasil.com.br DO FUSCA
49 TODOS OS CONTEÚDOS ESCRITOS POR COLABORADORES PUBLICADOS EM NOSSO VEÍCULO SÃO DE INTEIRA E TOTAL RESPONSABILIDADE DOS AUTORES QUE OS ASSINAM.
AO TESLA
O ar-condicionado deixou de ser um item de luxo, agora é um sistema de conforto e segurança
Em alguns veículos, se o ar-condicionado não estiver funcionando corretamente, o motor não dá partida para proteger os ocupantes e o próprio veículo, que depende deste sistema operando plenamente


Os veículos utilizados nos setores agrícola e pecuário possuem cabines e ficam expostos diretamente ao calor do sol e ao calor irradiado do motor e da transmissão em funcionamento, tornando o ar-condicionado uma prioridade para o operador. (Fig.1)
Nos veículos elétricos, o ar-condicionado é compartilhado e refrigera a cabine e o compartimento da bateria para manter a temperatura em torno de 20 graus Celsius, permitindo um tempo de uso mais longo das baterias, pois devem ser evitados os picos de temperaturas elevadas e baixas. (Fig.2)
Nos veículos de uso diário como os carros e caminhões, o sistema de ar-condicionado garante temperaturas agradáveis e uma visão desimpedida sem vidros embaçados durante o ano todo.
Para a grande parte das pessoas que utilizam veículos para passeio ou trabalho, não sofrem mais com o frio ou ondas de calor, pois o sistema de ar-condicionado, que era considerado um luxo até há poucos anos, atualmente é um acessório que já vem de fábrica.


Na época de calor o sistema mantém o veículo agradavelmente fresco e na época de frio ou chuvas, mantém a umidade sob controle e os vidros livres do embaçamento, o que melhora a visibilidade mantendo a segurança ao dirigir. (Fig.3)
O sistema de ar-condicionado não é perfeito e deve ser utilizado e mantido adequadamente para garantir o seu melhor desempenho.
São poucos os condutores de veículos que conhecem o princípio de funcionamento de um sistema de ar-condicionado, sendo que a maioria quer o ar fresco quando estiver calor e ar aquecido quando estiver frio.

Quando estas funções básicas do sistema de ar-condicionado deixam de funcionar, é o momento de lembrar que as oficinas especializadas neste sistema existem e estão sempre à espera e preparadas para atender estes clientes.
O sistema de ar-condicionado funciona de acordo com um princípio semelhante ao de um refrigerador doméstico. No carro, o motor aciona o compressor através de uma correia poly V, comprime o fluido refrigerante, que fica quente neste processo. No condensador, o gás refrigerante é resfriado pelo fluxo de ar frontal e se torna líquido. Assim que a pressão no circuito de refrigeração cai e o refrigerante evapora novamente, ele esfria até cerca de 2 graus Celsius. Durante a transição para o estado gasoso, o calor é extraído do ar da cabine pelo fluido refrigerante, de modo que uma brisa fresca flui das aberturas de ventilação do painel para o interior do veículo. (Fig.4) Além de controlar a temperatura na cabine, o sistema de ar-condicionado tem uma função muito importante que é reduzir a umidade, que pode condensar a baixas temperaturas no evaporador e a água restante é descarregada ao ar
Antonio Gaspar de Oliveira agaspar@hotmail.com
e ilustrações: Gaspar Março 2024 • oficinabrasil.com.br TÉCNICA 50 1 2
Fotos
3


livre pelos dutos de drenagem.
O ar desumidificado não só torna mais suportável estar no carro em dias abafados, mas também evita o embaçamento dos vidros em épocas de chuvas ou de frio, além de evitar a formação de colônias de fungos e bactérias, que gostam de ambientes úmidos para se proliferar.
É provável que nem todos saibam, mas em temperaturas externas abaixo de 5 graus Celsius, o sistema de ar-condicionado desliga automaticamente.
Caso contrário, o compressor, responsável pelo desempenho de refrigeração poderá congelar o evaporador.
Nestas condições de temperaturas baixas, é recomendável limpar o para-brisas internamente, porque um para-brisas sujo retém mais as partículas de ar úmido e vai embaçar mais rapidamente do que em um para-brisas limpo. (Fig.5)
Carros de cor escura tendem a ficar mais quentes quando ficam expostos ao sol intenso e ao entrar no carro,


ar-condicionado ficar inativo durante muito tempo, as peças móveis ficam sem lubrificação e as vedações podem ressecar e ficar porosas, o risco de perda de fluido refrigerante aumenta e o óleo do compressor pode degradar.
é melhor abrir todas as portas e janelas para que o ar quente acumulado possa sair primeiro. Para baixar a temperatura no interior do carro o mais rapidamente possível, deve-se utilizar o modo de recirculação na capacidade máxima de refrigeração.
Mesmo não tendo necessidade de utilizar o sistema de ar-condicionado, é importante ativar o sistema para garantir sua funcionalidade e aumentar significativamente a vida útil do conjunto. Se o sistema de
Outra informação importante do sistema de ar-condicionado envolve a questão de saúde e de segurança. Com temperaturas elevadas dentro do veículo, faz a pulsação e a temperatura corporal aumentar e isso compromete a concentração e a diminuição do tempo de reação, que pode elevar os riscos de acidentes. (Fig.6)
Uma maneira simples que evita a formação de bactérias, fungos e odores é desligar a função de refrigeração do sistema de ar-condicionado pouco antes do final da viagem, deixando apenas a ventilação funcionando. Desta forma, não permanece no sistema nenhuma umidade residual que favoreça infestações bacterianas e fúngicas, bem como odores desagradáveis.
Germes, fungos e bactérias são invisíveis, mas se no interior do veículo começar a cheirar mal, é uma indicação da formação de colônias de bactérias e fungos no ambiente úmido, principalmente na superfície do evaporador. Para algumas pessoas com o sistema imunológico fraco, correm riscos, pois podem desenvolver reações alérgicas que vão desde rinite crônica até asma brônquica. . (Fig.7)
Em veículos de transporte coletivo como trens, metrôs e ônibus, os riscos de contaminação são potencializados pelos próprios usuários destes transportes devido à aglomeração, bastando apenas uma pessoa com doença respiratória para contaminar todos que estiverem no veículo de transporte.
Isso se agrava porque ao desembarcarem, a contaminação continua quando entrar mais pessoas devido ao sistema de ar-condicionado que ficou contaminado.
Março 2024 • oficinabrasil.com.br TÉCNICA 51 4 5 6 7
Diagnóstico e Manutenção avançada em DCUs –
Bombas de ARLA – Parte 4
Nesta série, estamos considerando algumas manutenções comuns nos sistemas mais aplicados no nosso país. Já se deparou com falhas envolvendo o sistema Denoxtronic 2.2? Confira agora uma manutenção nesse sistema

Quando uma luz acesa no painel ou um código de falha relacionado ao sistema SCR aparece, a causa real do problema pode ser qualquer elemento do sistema. De fato, esse é o grande desafio na manutenção dos sistemas de pós-tratamento SCR Euro 5 – não é possível, baseando-se na falha ou sintoma, condenar um dos componentes de imediato. É necessária uma ferramenta de análise especial para analisar elemento a elemento em busca da causa real do problema. Por exemplo, isolando a unidade de bombeamento do restante do sistema, para uma validação em bancada, é possível realizar testes de cada elemento eletrônico, eletromecânico e hidráulico do sistema interno para, através de uma sequência técnica e lógica, eliminar possibilidades até que chegamos a verdadeira causa do problema. Na quarta parte desta série de artigos, vamos considerar uma falha recorrente no sistema Denoxtronic 2.2. IMAGEM 1
REGIMES DE TRABALHO
DO
SISTEMA DENOXTRONIC 2.2
As conexões externas desse sistema são simples – entrada do reagente ARLA, saída do reagente para o dosador e o controle de retorno do reagente para o reservatório. Vale lembrar que no sistema Denoxtronic 2.2, diferente dos sistemas anteriores da família Denox Bosch, a ECU (Eletronic Control Unit) do sistema não está integrada à bomba. A ECU é um módulo à


parte, localizado em outro local do veículo. Descrição dos elementos de conexão externos: IMAGEM 2
1. Conexão de saída do ARLA “OUTLET”;
2. Conexão de retorno do ARLA “BACKFLOW”;
3. Conexão de entrada do ARLA “INLET”.
As características de trabalho do sistema Denoxtronic 2.2 se dividem em quatro regimes: (1) Regime de enchimento e geração de pressão; (2) Regime de manutenção da pressão de trabalho; (3) Regime de Injeção do ARLA e (4) Regime de “purga” do sistema. No primeiro regime, logo após a partida, a ECU do sistema aciona a bomba de diafragma. A bomba
de diafragma é acionada nesse momento inicial para atingir a pressão adequada do sistema, portanto, é acionada em alta rotação para succionar o ARLA do reservatório e o enviar para o filtro. Essa sucção ocorre através do duto “INLET”. A partir do filtro o ARLA segue para o duto “OUTLET” e para o dosador.


No segundo regime, quando o ARLA atinge dentro do sistema sua pressão nominal de trabalho, a ECU do sistema de pós-tratamento diminui a rotação da bomba de diafragma, uma rotação capaz de manter a pressão nominal. O excesso de ARLA gerado durante as oscilações de rotação da bomba retorna para o reservatório através do duto “BACK FLOW”. No terceiro regime, com o motor em funcionamento e com carga do motor (necessária para geração da temperatura adequada à reação química do reagente com os gases), a ECU do sistema irá determinar a quantidade de ARLA a ser injetada no fluxo dos gases, baseando-se nas seguintes informações e pré-requisitos: • Pressão do ARLA (entre
Março 2024 • oficinabrasil.com.br TÉCNICA 52
andremiura@chiptronic.com.br
André Miura
1
4
Fotos: André Miura
2 3


8,00 e 10,00 Bar);
• Temperatura do ARLA no reservatório;
• Nível do reservatório (deve estar acima de 5%);
• Temperatura dos gases antes do catalisador SCR (acima de 200°C);
• Informações de PPM (partículas por milhão) do sensor de Nox.
No final do trabalho do sistema, o quarto regime ocorre logo após o desligamento do motor. A ECU do sistema de pós-tratamento liga a eletroválvula direcionadora e aciona a bomba de diafragma em alta rotação novamente. O acionamento da eletroválvula direcionadora permite que a bomba de diafragma passe a succionar o ARLA do dosador e das conexões da bomba (filtro e retorno) de volta para o reservatório. Dessa maneira o ARLA não cristaliza dentro do sistema após desligamento, evitando entupimentos.
ELEMENTOS INTERNOS E FUNCIONALIDADES
Ao analisarmos a evolução da família Denoxtronic de bombas de ARLA percebe-se nitidamente uma diminuição na quantidade de
componentes internos e um maior aproveitamento da própria carcaça da bomba como elemento interno de passagem e direcionamento do reagente pelos elementos. Os elementos básicos são:
• IMAGEM 3:
1. Sensor de pressão do ARLA;
2. Eletroválvula direcionadora;
3. Bomba de diafragma;
4. Aquecedor do filtro do ARLA;
5. Filtro do ARLA;
6. Conector elétrico da Bomba.
IMAGEM 4:
1. Filtro do ARLA;
2. Eletroválvula direcionadora;
3. Aquecedor da entrada da válvula.
FALHA COMUM NO SISTEMA
Uma falha muito comum neste sistema é o corrompimento das trilhas elétricas internas. Diferentemente dos sistemas anteriores da família Denoxtronic, em que encontramos um chicote elétrico feito por fios e conectores, no sistema Denoxtronic 2.2 temos um barramento fixo de comunicação

e ligação entre os elementos internos. Esse barramento de material condutor possui trilhas bem finas de conexão entre os pontos, além de pontos de pressão e solda de fábrica. Isso em si não seria um problema, porém como temos falhas normais nas bombas de diafragma, como por exemplo, desgaste nas membranas e vedações, há vazamento de reagente ARLA no interior do sistema com frequência. Isso gera zinabre e oxidação nos barramentos, que por serem muito finos, se rompem facilmente. Isso ocasiona falta de funcionamento de vários elementos elétricos e falha geral no sistema. IMAGEM 5
Felizmente é possível realizar a substituição desse barramento e restabelecer o funcionamento elétrico do sistema. O desafio: o barramento original é fixado na carcaça plástica através de rebites plásticos, fundidos no barramento. Portanto, é necessário desgastar esses pinos para extrair o barramento original. Além disso, os pontos de conexão entre o barramento e as peças possui uma fixação por pressão de fábrica. Para substituir por um novo barramento é necessário realizar furações entre os contatos para usar pequenas porcas e parafusos. IMAGEM 6
Ao final das manutenções, a fim de excluir qualquer possibilidade de falha no veículo, podemos usar uma ferramenta de análise especial para verificar os elementos internos e um teste completo de dosagem. Isso inclui geração das pressões, dosagem na quantidade certa de reagente e purga adequada. IMAGEM 7

Março 2024 • oficinabrasil.com.br TÉCNICA 53 INFORME PUBLICITÁRIO
INTEIRA
TODOS OS CONTEÚDOS ESCRITOS POR COLABORADORES PUBLICADOS EM NOSSO JORNAL SÃO DE
E TOTAL RESPONSABILIDADE DOS AUTORES QUE OS ASSINAM.
7
André Miura é Diretor e proprietário da Chiptronic Tecnologia Automotiva 5
6


OFórum do Jornal Oficina Brasil se consagra entre os reparadores como o maior sistema de troca de informações entre profissionais do país! São mais de 130 mil profissionais cadastrados debatendo, dando dicas e sugestões para resolver os problemas mais complicados. Participe você também! Para tanto, basta cadastrar-se em nosso site. Um dia você ajuda um colega e no outro é ajudado! Confira abaixo os casos que mais se destacaram neste mês.
Parati 1990 - Problemas de funcionamento no motor AP
DEFEITO: O
reparador Marcos

Rodrigues deparou-se com um desafio considerável ao lidar com uma Parati equipada com motor AP 1.8. Após a queima da junta do cabeçote, que causou a mistura de água no óleo, o desempenho do motor estava comprometido, persistindo mesmo após a retífica. Mesmo após minuciosos testes e verificações dos componentes, incluindo combustível, ignição, cabos e bobinas, o veículo não demonstrava sinais de retorno ao funcionamento adequado.
DIAGNÓSTICO: Inicialmente, o veículo apresentava problemas graves, incluindo a queima da junta do cabeçote, resultando na presença de água misturada no óleo. Nessas condições, o motor não estava funcionando corretamente, mal conseguindo operar. Após realizar o serviço de retífica e a montagem cuidadosa, seguindo os procedimentos corretos, o motor foi restaurado à sua condição original. No entanto, o problema persistiu: apesar de todos os componentes estarem corretos e a montagem estar conforme o esperado, o motor continuava a se recusar a funcionar adequadamente. Embora houvesse centelha nos cilindros, combustível suficiente e a ordem de ignição estivesse correta, o motor ainda falhava. Testes adicionais foram realizados, incluindo a substituição
das velas e cabos, verificação da bobina e do distribuidor, bem como a medição da compressão dos cilindros, que se mostrou em torno de 12 bar. Mesmo quando o motor conseguiu ser colocado em funcionamento em um determinado momento, ele operava com falhas significativas, como se estivesse operando com apenas dois cilindros.
Após examinar todos os componentes e realizar testes, o reparador observou que o motor não funcionava corretamente, apresentando falhas significativas e excesso de combustível. A compressão dos cilindros estava abaixo do ideal, o que levantou preocupações sobre a eficiência do motor.
Sem ter mais ideias, o reparador decidiu abrir um tópico no fórum para tentar resolver a dor de cabeça que estava enfrentando em sua oficina mecânica. Rapidamente, colegas de profissão se mobilizaram para auxiliá-lo. Leonardo Aparecido sugeriu que Marcos verificasse a polia de comando e se certificasse de que o escapamento não estivesse
obstruído.
Em poucos minutos, os especialistas do fórum se uniram para ajudar o reparador. A primeira orientação foi checar se o escapamento estava entupido, mas Marcos já havia investigado essa possibilidade. O segundo reparador sugeriu a troca dos anéis, pois eles costumam travar, resultando na perda de compressão do motor. Além disso, o colega alertou que a compressão do carro estava significativamente baixa, sendo ideal que estivesse entre 180 e 200 bar.
SOLUÇÃO: Contando com a colaboração de outros reparadores na comunidade, ele investigou diversas hipóteses, desde possíveis falhas no distribuidor até problemas nos anéis do pistão. Contudo, ao realizar uma minuciosa revisão no carburador, identificou que os giclês estavam dimensionados acima das especificações recomendadas. Após substituir os giclês e realizar a devida regulagem do carburador, o problema foi solucionado e o motor voltou a operar normalmente.
Fiat Argo com luz de partida a frio piscando

DEFEITO: O veículo durante a partida, começava a piscar a luz de partida a frio, no entanto, o carro não entrava em funcionamento. Ao analisar a situação, o reparador procedeu com a substituição da flauta completa e do módulo de injeção do Argo. No entanto, mesmo após essa intervenção, a luz de partida a frio persistia em piscar, indicando uma falha contínua no sistema.
DIAGNÓSTICO: O reparador recorreu ao Fórum, confiante de que seus colegas poderiam oferecer insights para desvendar esse caso complexo. O primeiro especialista sugeriu que o código “final 00” indicava um circuito aberto, possivelmente causado por um fio quebrado ou mau contato. Recomendou, inicialmente, a verificação da bateria e, em seguida, do sistema de aterramento. Um terceiro colaborador compartilhou os códigos de falha registrados: P16B8-00 (Falha no circuito elétrico de comando do sistema de partida a frio) e P16BB-00 (Falha no circuito elétrico do sinal do sistema de partida a frio). Além disso, aconselhou uma análise minuciosa do chicote
elétrico em busca de possíveis mau contatos ou fios quebrados.
O quarto reparador, renomado no Fórum, o Professor Scopino, sugeriu que o problema poderia estar relacionado a um chicote com mau contato, resistência anormal nos injetores ou até mesmo incompatibilidade de software no módulo.
Em meio a essa busca pela solução, o reparador procedeu à verificação da continuidade dos fios na tomada do aquecimento, assegurando a presença do sinal PWM negativo ou +B. Examinou o diagrama elétrico do veículo meticulosamente para rastrear o sinal que alcança o sistema de partida a frio.
SOLUÇÃO: Apesar de terem sido testadas duas centrais anteriormente, o problema só foi resolvido com a instalação de uma nova central eletrônica, sugerindo a possibilidade de incompatibilidade de software com os componentes substituídos anteriormente.
Com a nova central eletrônica instalada, o problema foi resolvido.
#JUNTOSRESOLVEMOS 54 Março 2024 • oficinabrasil.com.br
Divulgação
Fotos: Divulgação

Chevrolet S10 2.8 Diesel– com problema de código P0101
em descida
DEFEITO: O veículo chegou na oficina apresentando o código de defeito P0101 em uma Chevrolet S10. O reparador notou que a falha ocorria especificamente em descidas, quando o condutor retirava o pé do acelerador.
DIAGNÓSTICO: Diante da incerteza sobre como proceder, o reparador recorreu à verdadeira rede social dos profissionais da reparação, o Fórum Oficina Brasil, e criou um tópico para compartilhar o desafio que enfrentava. Em questão de segundos, a primeira sugestão chegou, indicando que o código de defeito estava possivelmente relacionado ao sensor MAF (fluxo de ar) e aconselhando uma análise mais aprofundada desse componente. O reparador prontamente tentou substituir o sensor MAF, realizando também uma verificação minuciosa das mangueiras do sistema e da válvula EGR.
Outro participante do fórum re -
comendou a utilização da máquina de fumaça para identificar possíveis vazamentos nas mangueiras, além de verificar as leituras do sensor MAF em marcha lenta e a 2.500 rpm. No entanto, apesar dessas medidas, o carro ainda não retomava o funcionamento normal.
Um terceiro reparador sugeriu acompanhar as leituras do sensor MAF utilizando um scanner, visando identificar variações durante a ocorrência da falha. Apesar dos esforços, a solução para o problema ainda se mostrava desafiadora.
SOLUÇÃO: Após inúmeras tentativas de diagnóstico e considerando as sugestões da comunidade, o reparador implementou diversas medidas para abordar o problema. Além da substituição do sensor MAF, ele conduziu uma limpeza no coletor e a substituição das molas das válvulas do terceiro

cilindro. O reparador esclareceu que a válvula EGR estava direcionando o fluxo para esse cilindro, resultando em uma carbonização mais intensa comparada aos demais, e a fragilização das molas contribuía para a medição incorreta do ar admitido. Isso, por sua vez, originava o código de defeito P0101 e uma leve emissão de fumaça branca. Essas intervenções revelaram-se eficazes, resolvendo de maneira satisfatória o problema e garantindo o correto funcionamento do motor.
GM Cruze - Consumo excessivo de óleo após retífica
DEFEITO: O sedã da montadora americana permaneceu parado na oficina mecânica por alguns dias, pois o reparador havia realizado uma usinagem no veículo. No entanto, após a conclusão desse procedimento, o carro passou a apresentar um consumo excessivo de óleo.
DIAGNÓSTICO: O profissional já havia desmontado o motor para uma nova verificação, mas não encontrou nenhuma anomalia aparente. Sem compreender mais o que poderia estar ocasionando o consumo excessivo de óleo, ele recorreu ao Fórum em busca de soluções. Em poucos minutos, as sugestões dos especialistas começaram a chegar.
Um dos reparadores propôs medir as camisas do motor, verificar o brunimento e a
rugosidade das superfícies das peças, e examinar as guias e retentores de válvulas. Mas, mesmo assim o carro continuava sem pegar.
Outro profissional sugeriu testar a vazão e verificar o respiro do motor quando este estivesse aquecido. Mas, o problema persistia. Sabemos que tempo na oficina é dinheiro, e o reparador só queria solucionar este caso o quanto antes.

como uma possível fonte de irregularidade.
O Professor Scopino, diante deste caso, alertou para possíveis problemas além da parte interna do motor, destacando o diafragma do respiro
SOLUÇÃO: Após seguir algumas recomendações da comunidade, o reparador regressou para comunicar que o problema fora solucionado. A falha residia nos anéis do motor, os quais foram substituídos, juntamente com a
tampa das válvulas. Mesmo que o diafragma não apresentasse perfurações, notou-se que a borracha estava mais macia do que o normal, o que contribuiu para a questão. A substituição destas peças foi eficaz na resolução do problema de consumo excessivo de óleo.
Participe!
Estas matérias, extraídas de nosso fórum, são fruto da participação dos reparadores que fazem parte da grande família chamada Oficina Brasil.
Acesse você também o nosso Fórum e compartilhe suas experiências com essa comunidade.
Lembre-se, o seu conhecimento poderá ajudar milhares de reparadores em todo o Brasil e seu nome será publicado nesta seção.
Saiba mais em: www.oficinabrasil.com.br

55 Março 2024 • oficinabrasil.com.br DIRETO DO FORUM











































@ngkntkbrasil


















































































































 Pedro Luiz Scopino scopino@automecanicascopino.com.br
Pedro Luiz Scopino scopino@automecanicascopino.com.br






































 Marcio Cattani
Instagram: @marciocattani marcio.cattani@masterpower.com.br
Marcio Cattani
Instagram: @marciocattani marcio.cattani@masterpower.com.br
































































 Professor Scopino, Mecânico de Autos Profissional e Embaixador da marca Pierburg no Brasil
Professor Scopino, Mecânico de Autos Profissional e Embaixador da marca Pierburg no Brasil